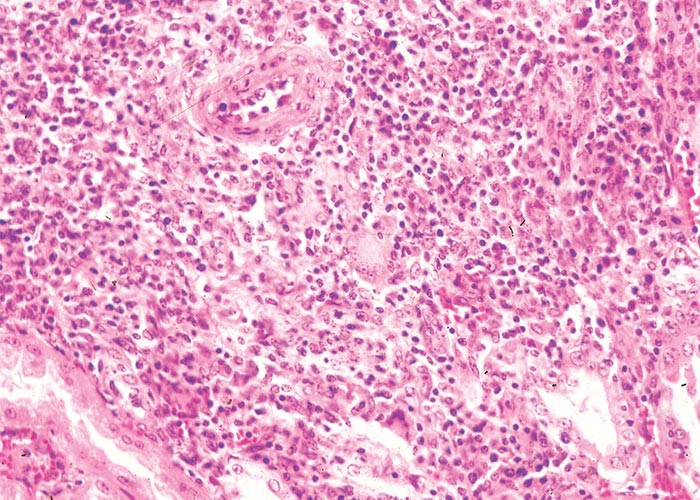
Urogenital system

Urogenital system
| Nephropathy | Primary Nephropathy: Quercus robur | Anagallis arvensis | Nolletia gariepina | Aspergillus spp. and Penicillium spp. Secondary Nephropathy |
| Bladder | Pteridium aquilinum | Pithomyces chartarum |
| Reproductive System | Salsola tuberculatiformis | Trifolium spp. | Fusarium graminearum |
This content is distributed under the following licence: Attribution-NonCommercial CC BY-NC  View Creative Commons Licence details here
View Creative Commons Licence details here

Introduction
Apart from infectious agents, certain drugs and heavy metals, a number of poisonous plants and mycotoxins affect the urogenital system of stock in southern Africa. In this chapter, the phyto- and mycotoxicoses of the urogenital system are divided into four categories: those in which the kidneys are primarily affected (primary nephropathy); those where the main effect is elsewhere in the body and the kidneys are secondarily involved (secondary nephropathy); those conditions in which the urinary bladder is implicated and poisonings which have a bearing on the reproductive system and/or the developing foetus.
Primary Nephropathy
Soluble oxalate poisoning
Oxalate poisoning in stock is characterized by nephrosis, hypocalcaemia, gastrointestinal stasis, depression, coma and sometimes also widespread haemorrhages. This kind of poisoning occurs worldwide and has been associated with a number of plant species32, 41, 69, 78, 91, 139 and with the consumption of mouldy feed.7, 32
In South Africa the plants listed in Table 1 are regarded as of importance in oxalic acid and soluble oxalate intoxication151, 162 (T.W. Naudé & T.S. Kellerman, ARC-OVI, personal observation, 1996).
Table 1 Some plants in southern Africa that contain oxalates
| Plant Species | Family | Common Name |
| Opuntia spp. | Cactaceae | prickly pear, turksvy |
Numerous Oxalis and Rumex species (Figures 1 and 2) occur in South Africa but of these only two Oxalis spp. are major weeds, infesting orchards, vineyards and lands. They are both stemless herbs with characteristic trifoliate leaves and sub-bilobed leaflets on long, usually glabrous petioles, arising from the ground. The five-merous funnel-shaped flowers are borne in many-flowered umbels on slender peduncles, which are usually longer than the petioles. The indigenous Oxalis pes-caprae, with its bright yellow flowers, is confined to the southern and south western coastal regions of the country (Eastern and Western Cape provinces), while O. latifolia with pink to mauve flowers are widespread further north (Figure 1).60 Trifolium clovers have almost identical leaves, but are distinguished from Oxalis by their racemes of pea-like flowers.
Rumex acetosella subsp. angiocarpus (Figure 2), a rhizomatous perennial growing up to 50 cm high, is a widespread troublesome weed on disturbed soil. The characteristic leaves have lanceolate blades (up to 5 cm long and 1–2 cm broad) and spreading basal lobes, giving them the appearance of a barbed spear. The leaves are arranged alternately on petioles of up to 6 cm long.60
Poisoning with O. pes-caprae and R. acetosella, which occurs extensively in the Winter Rainfall Area, is quite common (D.J. Schneider, Regional Veterinary Laboratory, Stellenbosch, personal communication, 1986) and an outbreak of R. acetosella poisoning has been diagnosed also in Mpumalanga (T.W. Naudé and R.C. Tustin, ARC-OVI, unpublished data, 1968).
It is noteworthy that Steyn151, 152 regards the succulent vygies or mesems (Figure 3) – which grow particularly abundantly in the semi-arid regions of the Northern Cape Province of South Africa and the southern parts of Namibia – as the plants most commonly associated with oxalate poisoning in sheep and goats, especially during times of severe drought.151, 152 Apart from oxalic acid and oxalates, many Mesembryanthemum spp. contain the alkaloid mesembrine, which has been associated with spasms in a rabbit after the subcutaneous injection of 0,45 g of the substance.151 Some of the sheep and goats poisoned with a Psilocaulon sp. showed strychnine-like convulsions, attributed to the alkaloid, psilocauline.130, 131, 149, 151, 152 Two rabbits, each of which received per stomach tube 50 g of wilted Psilocaulon sp. collected in the flower and fruit stages during August in the Willowmore district, showed restlessness, severely increased heart rate and respiration, and convulsions within one hour of dosage.151
Rhubarb, beetroot and spinach are common plants in many gardens throughout the world and constitute an important item of the human diet.78 Poisonings have been reported abroad in stock and people after the consumption of rhubarb blades which contain citric and oxalic acids.78
The tops and the roots of sugar beet are sometimes utilized as forage.78 Beetroot crops may vary in characteristics such as external colour (red or yellow), internal colour, the degree to which they grow within or above the ground and the dry matter content.78 Sugar beet tops (especially after treatment with the herbicide, 2,4-D) may contain toxic levels of nitrates in the foliage.78 Apart from nitrate poisoning in stock in the northern hemisphere, scouring and loss of animals have been attributed to oxalates after the feeding of beet tops. Hypocalcaemia and an increased coagulation time were reported in dairy cows following the ingestion of large amounts of fodder beet, and ruminal acidosis occurred in sheep subsequent to overeating on beetroot.78, 151
Chenopodium album is listed as a possible cause of oxalate poisoning by Clarke et al., (1981)32 and by Buck et al. (1976).18 At least one outbreak of intoxication in sheep has been attributed to this plant abroad.61 In South Africa, 4 out of 40 nursing cows developed signs of hypocalcaemia within 24 hours of being introduced onto a harvested wheat land heavily infested with C. album containing 16% oxalate (DMB). Intravenous calcium therapy resulted in uneventful recovery (T.W. Naudé ARC-OVI and E.W. Albertyn, Winburg, Free State, personal observation, 1995).
The succulent clathodes of Opuntia ficus-indica (Figure 4) (particularly the spineless variety) and leaves of Agave americana used for drought-feeding of stock in low rainfall areas, may both give rise to oxalate poisoning.152 The amount of oxalate in Opuntia spp. (Figure 4) may vary considerably at different times of the year and in different years.151, 158 Actinobacillosis of the lips and caseous lymphadenitis secondary to mechanical damage have also been associated with the feeding of the spiny prickly pear158 (see The skin and adnexa).
Cenchrus ciliaris (blou buffelsgras) and Setaria sphacelata var. sphacelata (bristle grass, particularly the Kazangula and Bua River strains), are indigenous grasses58 cultivated worldwide as forage. Although no problems with these grasses have been experienced in South Africa, soluble oxalate poisoning has been reported in stock grazing both C. ciliaris95 and S. sphacelata138 in Australia.
Oxalic acid is an organic dicarboxylic acid, the principal soluble salts of which are sodium, potassium and ammonium oxalate. It readily forms insoluble salts with calcium and magnesium7, 69, 172 (Figure 5). Intraruminal oxalate may be degraded by rumen bacteria, especially those that have been preconditioned, to carbon dioxide and formate. The hydrogen from formate is toxic to the oxalate degrading system, but it is removed through methanogenesis to synthesize methane.4, 22
Oxalate can bind with calcium in the rumen to form insoluble calcium oxalate which cannot be absorbed and is excreted in the faeces; or the oxalate may be absorbed from the rumen and bind with calcium in the blood, giving rise to hypocalcaemia which interferes with body and enzymatic processes.32, 70, 73, 169 The insoluble calcium oxalate can crystallize in various tissues, especially the kidneys and rumen wall.69 Detoxification of oxalates by microorganisms in the rumen may be impaired by a high oxalate intake over a relatively short period and oxalate poisoning may result.69 James69 pointed out that gastrointestinal motility stops shortly after feeding on a lethal dose of an oxalate-containing plant, Halogeton glomeratus, limiting the total amount of oxalate absorbed. According to James,69 a sheep will be fully conditioned after about four days of feeding with low doses of oxalates, and the lethal dose will be increased by c.30%. Plants must contain 10% or more oxalic acid on a dry-weight basis to be potentially dangerous.69 Animals find oxalate-containing plants palatable, and intoxication in southern Africa is confined mainly to sheep. Two main syndromes are encountered: firstly, hypocalcaemia-nephrosis, in which the detoxification mechanism even of adapted animals is overcome by the ingestion of large quantities of oxalate-containing plants; secondly, a calcium deficiency may result from the continuous ingestion of small amounts of oxalates. Oxalates may also play a role in the formation of kidney and bladder stones.
Cattle, sheep and horses differ in their response to oxalates.69, 73 Although sheep and cattle are equally susceptible to experimental poisoning, cattle are less commonly affected than sheep under field conditions.73 Horses are apparently resistant to oxalate-induced nephrosis and will develop a fatal acute gastroenteritis only after receiving unnaturally high levels of oxalates.73 In Australia, a mineral imbalance resulting in a degenerative condition of the bones (Osteodystrophia fibrosa) in horses has been associated with prolonged exposure to pastures containing low levels of oxalates.166
Acute, subacute and chronic oxalate poisoning have been described in stock.7, 41, 69, 91, 139, 151 Acute poisoning is characterized by hypocalcaemia, reduced ruminal motility, depression, weakness, coma and, occasionally, tetany.32, 68, 69, 91 Although deaths in acute cases have generally been attributed to hypocalcaemia and the effect it has on body processes and on enzymes activated by calcium and magnesium, interference with energy metabolism through inhibition of oxidative phosphorylation, succinic dehydrogenase and the reduction of lactate also seems to be important.69, 172 Gastrointestinal stasis, and haemorrhagic rumenitis and shock, which have been associated with certain oxalate-containing plants, may contribute to death.69 James69 and Dickie et al.41 pointed out that the occlusion of renal tubules by crystals is not an essential feature of oxalate nephrosis.
On the other hand, subacute and chronic oxalate poisonings have been ascribed to renal dysfunction and to uraemia from kidney damage following mechanical blockage and damage of renal tubules by oxalate crystals.69 Clinically affected animals are depressed and lethargic and may move with a stiff gait before they become recumbent and die.69 At necropsy, the kidneys are usually moderately to severely enlarged and have a light-brown to greyish-brown colour. On cut sections, the parenchyma is more moist than normal, and often has a fine chalky-white striated appearance. Deposits are often visible, especially at the corticomedullary junction and in the medulla. Scrapings from the cut surface, viewed under polarized light, reveal birefringent crystals. Other macroscopical changes include effusion of the body cavities (sometimes exceeding several litres of ascitic fluid), lung oedema and, in severe cases, perirenal oedema, and oedema of the gastrointestinal wall particularly in the rumen and abomasum and changes compatible with uraemia.32, 69, 73, 139 Microscopically, calcium oxalate crystals are most often present in the lumen of renal tubules causing tubular obstruction and damage (Figure 6). Crystals have also been reported in the lumen and wall of blood vessels in the rumen and brain associated with vascular necrosis and haemorrhage.18, 69, 73, 139, 165 During processing of renal tissue for histopathology, the crystals may wash from sections, so oxalate crystals are sometimes best demonstrable in frozen sections, stained with haematoxylin and eosin and viewed under polarized light.41 Other noteworthy renal changes include prominent tubular dilatation, numerous hyaline and a few cellular casts, interstitial oedema and, in the longer standing cases, also a few scattered foci of mononuclear cells, fibroplasia and evidence of regeneration of the lining epithelium in some tubules.
Animals affected in the hypocalcaemic stage of acute oxalate poisoning may be treated with calcium borogluconate but therapy is usually of little help in those cases suffering from effects of calcium oxalate deposition in the kidneys. Poisoning of sheep on oxalate-containing pastures can be prevented by supplying them with dicalcium phosphate at 25% of the usual salt lick. Time should also be allowed for animals to be conditioned to oxalate pastures by providing supplementary hay for a few weeks or by rotating them to non-oxalate pastures.32
Quercus robur L. (Fagaceae)
English oak, akkerboom, eikeboom
Quercus spp. cause severe nephrosis and gastroenteritis especially in cattle, but also in sheep and horses throughout the world.6, 55, 111, 117, 134 Pigs do not seem to be affected and ingest acorns with impunity. In South Africa, poisoning occurs in cattle111 mainly on the Highveld and in the Western Cape provinces where introduced Quercus spp. are planted as ornamental trees, windbreaks or to provide shade for stock (Figure 7). Quercus robur is probably the commonest of the many species cultivated in South Africa.
Although there is still some doubt with regard to the toxin(s) in Quercus spp., tannins or their metabolites (polyphenols) are most likely the toxic principles.6, 117 Digallic acid is the major active principle derived from the polyhydroxyphenolic moiety of oak tannins.6 Digallic acid is then converted to gallic acid and pyrogallol by bacterial fermentation in the gastrointestinal tract. Both are reducing agents and contribute to toxicosis. Rabbits, dosed with tannic acid, pyrogallol and gallic acid, developed a disease similar to that induced by Q. havardii.45 In North America, there are more than 60 species of oak trees, while in South Africa about 16 introduced Quercus spp. have been identified by the National Herbarium in Pretoria.111
Quercus spp. are large deciduous trees, generally bearing conical acorns 30–50 mm long and 10–20 mm thick. The leaves are variable but are usually simple and deeply lobed as in Q. robur. Kingsbury78 suggested that all the species should be regarded as potentially toxic, notwithstanding the fact that acorns can at times be ingested by stock with impunity.111 The buds, leaves, twigs and acorns have been associated with poisoning in animals,44, 117 and outbreaks of poisoning often follow large acorn crops, windstorms and rain.111, 159 Young leaves and recently fallen green acorns would appear to be more toxic than mature leaves and dry acorns.117, 143 As the leaves mature there is a marked reduction in their tannin content.123 In South Africa intoxication has been experienced only in cattle ingesting acorns.
Cattle, sheep, goats, rabbits and guinea-pigs have been poisoned experimentally with fresh, frozen or dried blossoms, buds, leaves and twigs of Q. havardii.117 Young cattle less than two years old are more susceptible to poisoning than older animals.31, 33, 111, 117 Pigs and birds are apparently resistant to poisoning.6, 111 Acute toxicity was induced in two young bovines that received 6–7 kg whole acorns over two days and died two days later after showing signs of abdominal pain, a profuse brown diarrhoea and dehydration.134 Massive hepatic necrosis and haemorrhage, but no significant renal lesions were noted in these two animals. Subacute poisoning, characterized by similar clinical signs to those described in cases with acute toxicity, followed after two six-month-old heifers were given 3,5 kg of ground acorns divided into two doses daily for six days. One animal died on Day 6 of the experiment and the other sick animal was sacrificed the following day.134 In this case, in addition to necrosis of the convoluted tubules and hyaline and granular casts in the kidneys, the liver showed centrilobular and/or midzonal necrosis. In South Africa, only the nephrotoxic syndrome has been reported.
Outbreaks of poisoning in cattle are often associated with poor grazing conditions.33 Some animals apparently develop a special taste for acorns and will eat them to the exclusion of other food.33, 117 In South Africa, outbreaks generally occur during autumn and winter when fallen acorns are readily available.111 In cattle, the clinical signs appear four to nine days after the consumption of acorns and include anorexia, depression, rapid loss of condition, staring coat, signs of abdominal pain, grinding of the teeth, dehydration, polydipsia, polyuria, and constipation followed by a brown, fetid diarrhoea often containing clots of mucus and blood. Fragments of acorns may be present in the faeces. Later, the breath of severely affected animals will develop a urinose odour, and there is subcutaneous oedema of the submandibular area, neck and ventral parts of the body.55, 111, 117, 134, 143, 159 In acute and subacute poisonings, death usually follows from one day to three to four weeks after the onset of the first clinical signs.111, 117 Chronic disease often manifests itself as a protracted, debilitating illness as a result of renal dysfunction.117, 143 The mortality rate in affected animals can be as high as 85%.117 Blood chemistry of clinical cases reveals marked elevations of the serum urea and creatinine, hypoproteinaemia and reduced levels of sodium and chloride.55, 117 Urinalysis shows mild to moderate proteinuria, granular and cellular casts, glycosuria, and the specific gravity is always very low.117 Milk of lactating cows may be bitter and unusable.13
Macroscopical lesions in cattle are almost entirely confined to the kidneys and alimentary tract.55, 111, 117, 134, 143, 159 The kidneys are swollen, greyish-yellow, moist on cut surface and numerous whitish foci c.1–2 mm in diameter (Figure 8), and sometimes also petechiae are scattered throughout the cortices. Perirenal oedema is often severe in acute and subacute cases, while in chronically affected animals the kidneys are smaller than normal, the parenchyma may have a spongy to honeycomb appearance, the consistency is increased and the cortical surface is irregular or roughened.55, 117 Multifocal haemorrhages, erosions and ulcerations may be visible throughout the digestive tract (Figure 9), but are most common on the mucosal surfaces of the mouth, including the tongue, and oesophagus.111, 117, 134, 143 Other noteworthy lesions include subcutaneous oedema of the ventral parts of the body, ascites, hydrothorax, hydropericardium and mesenteric, abomasal and intestinal oedema. Desquamated mucosa, blood and clots of mucus are sometimes evident in the foul-smelling fluid contents in the abomasum and small and large intestines. In addition, a strong ammonia odour may emanate from the abomasum and colon.111
The microscopical kidney lesions of oak poisoning in cattle have been well studied.55, 111, 117, 134, 143 The principal lesion is necrosis particularly of the proximal convoluted tubules (Figure 10), followed by interstitial oedema, mononuclear cell infiltration and fibrosis, tubular dilatation and regeneration of the lining epithelium of some tubules. Many yellowish-brown, lipofuscinous pigment granules are evident in necrotic tubular epithelial cells, as well as in cellular and hyaline casts in the cortex and medulla (Figure 10). Fibrinoid degeneration of the walls of small arteries and thrombosis often accompany the necrotic lesions in the alimentary tract.111, 134 In addition to the toxic effect, tannins or their metabolites may have on the gastrointestinal tract, some authorities are of the opinion that the consequent uraemia in oak poisoning may be a significant contributory factor in the production of the oedematous, haemorrhagic and necrotic lesions in the alimentary tract of severely affected animals.111, 134 These lesions (Figure 9) and the associated clinical signs in oak poisoning have in the past been confused with similar signs and changes seen in the mucosal disease/viral diarrhoea complex in cattle.111, 134, 143
There are only a few reports of oak poisoning in horses.6 Poisoning is characterized by restlessness, signs of colic and shock. The loose haemorrhagic faeces contain many acorn husks. At necropsy there is effusion of body cavities, marked gastrointestinal and mesenteric oedema, mucosal petechiation of the stomach and small and large intestines, as well as multifocal ulcerations in the caecum and colon. The kidneys are pale and swollen, with petechiae scattered throughout the cortices, while the microscopical lesions are marked by multifocal vacuolar degeneration and coagulative necrosis of the epithelium of proximal convoluted tubules, tubular dilatation, cellular and hyaline casts, oedema of the interstitium and hypercellularity of glomeruli.6
Treatment of oak poisoning in animals is symptomatic, but of questionable value.111, 117 Supplemental feeding of pastured animals during hazardous periods will limit intake of toxic plant material and consequently reduce the probability of poisoning6. Losses will be further reduced if calcium hydroxide is added at a rate of 15% by weight to the supplementary feed.44 The occasional animal will refuse to eat this mixture, but animals have never failed to eat a ration containing calcium hydroxide at a concentration of 10% or less.44
The kidney and associated lesions in oak poisoning should be differentiated from similar lesions described for the overdose effects of two nephrotoxic derivatives of carbanilide, namely, imidocarb and amicarbalide, which are used as babesiacidal drugs in cattle and horses and as anaplasmacidal drugs in cattle.40
Anagallis arvensis L. (Primulaceae)
Bird’s-eye, poor man’s weatherglass, shepherd’s weatherglass, pimpernel, scarlet pimpernel
Anagallis arvensis is an introduced weed rarely responsible for severe nephrosis in sheep.135
It is a prostrate to suberect annual herb growing c.100–300 mm tall, with much-branched, four-angled stems and slender roots. Small, bright-green, ovate, and sessile leaves are oppositely arranged and clasp the stems at their bases. Solitary, bright-blue, brick-red or pink flowers are borne on slender pedicles (Figure 11). The fruits are globose capsules, c.5 mm in diameter, which open with transverse slits so that the upper half falls off as a cap. Many 1 mm long, brownish, three-angled seeds are contained in these fruits.
Anagallis arvensis is native to Europe and Asia, but has become cosmopolitan and is often found in gardens and disturbed soils alongside roads and waste places.60 The weed occurs throughout South Africa (Figure 12), but poisoning of sheep has been confined to the Winter Rainfall Area of the Western Cape Province.135 The first outbreaks of poisoning occurred in the Tulbagh and Caledon districts where sheep had been grazing on fallow lands.135
Schneider135 poisoned three sheep with fresh and dried plants. One animal received four daily doses of fresh plant material at 20 g/kg and died on Day 7 of the experiment, while another sheep which was dosed 32 times with fresh and dried A. arvensis at a level of 2,2–4,2 g/kg/day, was sacrificed in extremis on Day 55 of the trial. The toxic principle of the plant is not known.
The morbidity and mortality in the flocks of sheep in the two reported outbreaks were c.15%. Affected animals showed anorexia, weakness and depression, and walked slowly with a stiff-legged gait before they went into lateral recumbency and coma. Death occurred within 24–36 hours after the appearance of the first signs. Chemical pathology revealed a marked rise in serum urea and magnesium levels and a decrease in serum calcium levels in both natural and experimental cases.135
At necropsy all the affected animals showed a severe nephrosis, characterized by reddish-brown to pale-grey discolouration of the parenchyma, petechiae throughout the cortex and marked perirenal oedema. Other noteworthy changes included a severe ascites, hydrothorax, subcutaneous oedema of the ventral abdomen and sometimes also oedema of the abomasal folds and mesentery. Microscopically, significant lesions were confined to the kidneys, and comprised coagulative necrosis of the proximal convoluted tubules, fatty degeneration of the distal convoluted tubules and cellular and protein casts in many tubules. Greenish-brown pigment in the tubular epithelium, as well as cellular casts and evidence of epithelial regeneration, interstitial oedema and fibroplasia were seen in the cases that had a more protracted course.135
Subsequent to these outbreaks135 only one other outbreak was ever diagnosed, coincidentally on the same farm at Caledon. This incidental intoxication appears to be associated with unseasonal rain which favours this plant’s growth when little other green grazing is available (D.J. Schneider, Wellington, personal communication, 1998).
Nolletia gariepina (DC.) Mattf. (Asteraceae)
Nolletia
This much-branched perennial shrub is 200–600 mm tall with brown or reddish-brown bark. The alternately arranged leaves are sessile, narrowly oblanceolate to obovate to linear. The yellow flowers can be found all year round, but with peaks from March to May, and again from August to October47 (Figure 13).
Ingestion of this woody shrub has induced nephrotoxicity in cattle. Two outbreaks occurred in the Kalahari Sandveld, Kuruman district, Northern Cape Province following exceptionally heavy rains. A mortality rate of 18% was estimated. In both field outbreaks the cattle were kraaled and deprived of feed for 24–36 hours before they were released into the camps where N. gariepina grew abundantly.47, 48
The cattle were depressed and weak, with anasarca of the perineal region, sometimes extending cranially along the ventral abdomen. Oedema of the eyelids and conjunctiva was occasionally present. Blood analysis revealed increased serum urea and creatinine concentrations.47, 48
At necropsy, all animals exhibited yellow-tinged subcutaneous oedematous fluid in the perineal area, ascites and perirenal oedema. The renal cortices were very pale, almost cream-coloured.47, 48
Histologically the renal lesions ranged from diffuse moderate degeneration to severe multifocal to coalescing, and in some cases almost diffuse, necrosis of tubular epithelial cells, especially of the proximal convoluted tubules in the cortex. Eosinophilic granular cellular and hyaline protein casts were present in the lumens of tubules (Figure 14). The hepatic lesions varied from mild to moderate hydropic degeneration to periportal and bridging coagulative necrosis of hepatocytes.47, 48
The toxicosis was successfully reproduced in three cattle. Following feed deprivation for 24 hours, acute toxicity was induced by intraruminal administration of dried, milled plant material at 3 g/kg body weight. Chemical pathology parameters in the experimental cases indicated renal and, to a lesser extent, hepatic damage, with increased serum urea and creatinine concentrations and raised aspartate aminotransferase (AST) and γ-glutamyl transferase (GGT) activities. Increased urinary sodium and potassium concentration and GGT activity, as well as proteinuria, were detected. The histological and electron microscopical examinations revealed acute renal tubular epithelial cell degeneration and necrosis, especially of the proximal convoluted tubules, with the basement membranes intact. Mild hepatocellular degeneration was also noticed.47
Sheep are also susceptible. In an experiment 4 out of 7 sheep died acutely or were euthanazed following dosing of 3 g/kg dried, milled plant material. On the other hand, administration of 1,5 g/kg elicited no clinical signs and 2,25 g/kg only induced mild clinical signs (R. Meintjes, C.J. Botha, L. Prozesky, Faculty of Veterinary Science, University of Pretoria, unpublished observations, 2003).
Aspergillus spp. and Penicillium spp. (Fungi: Hyphomycetes)
Mycotoxic nephropathy, associated with several Aspergillus and Penicillium spp., commonly affects pigs in Scandinavian countries.23, 30, 51, 81, 83, 87, 97, 122, 155 In South Africa, at least two outbreaks of porcine nephropathy, indistinguishable from cases reported abroad, occurred recently after the consumption of mouldy maize mixtures (J.A.W. Coetzer and T.S. Kellerman, ARC-OVI, unpublished observations, 1986).
Of all the Aspergillus and Penicillium spp. known to produce ochratoxin A (OA) (Figure 15) and citrinin (Figure 16) it would seem that A. ochraceus and P. viridicatum are most regularly associated with outbreaks of poisoning.23, 35, 81–83, 156 However, not all strains of these two species are producers of OA.23 Apart from being nephrotoxic, OA is also slightly hepatotoxic.128, 155, 156, 163
Ochratoxin A is a dihydroisocoumarin derivative, linked through its 7 carboxy-group to L-betaphenylalanine.23, 86 It is a fairly stable compound and some loss in toxicity occurs with time under storage conditions.23 Apart from OA, which is the major metabolite both in respect of occurrence and toxicity, other ochratoxins designated B, C and D, as well as penicillic acid, hydroxyaspergillic acid and secalonic acid, are produced by these fungi.23 Various methods have been described to detect ochratoxin or its residues in feed and tissues.12, 23, 153 Aspergillus and Penicillium spp. are common contaminants of storage grains, especially maize, wheat, oats and barley.23, 35, 81–83, 97, 155, 156 OA-producing fungi have also been found on preharvested barley.90
Experimental toxicoses have been studied in a wide variety of species, including the rat, mouse, guinea-pig, dog, calf, sheep, goat, chicken and turkey.23, 79, 80, 128 However, field outbreaks of poisoning are limited to pigs, chickens and turkeys.23, 35 An outbreak of suspected mycotoxic nephropathy occurred in a piggery in South Africa near Lydenburg approximately two weeks after mouldy maize had been incorporated into the ration (J.A.W. Coetzer, T.S. Kellerman, W.F.O. Marasas and J.J. van der Lugt, ARC-OVI, unpublished observations, 1985). Twelve weaner pigs, which were disoriented for a brief period, went into lateral recumbency and showed paddling movements before they died. Necropsies performed on two of these animals and on two supposedly healthy pigs revealed large, unilateral, perirenal haematomas (c.150–200 mm in diameter), and the kidneys were mildly swollen and discoloured greyish-brown. The majority of pigs on this mouldy ration were listless and lost weight, 14 sows developed agalactia and some sows walked with an arched back. On withdrawal of the suspected ration, the general condition of the animals improved steadily. Twenty healthy weaner pigs were slaughtered at the local abattoir one month after the first mortalities occurred on the farm. The carcases of all the animals were in good condition, but the kidneys of five pigs showed severe chronic lesions. In one pig, the kidneys were small and fibrotic while in the others they were enlarged, and the fibrosis and varying sized cysts throughout the parenchyma gave the cortical surface an uneven appearance. The kidneys of the other slaughtered pigs revealed a few multifocal, sunken scars or small whitish areas. Microscopically, the kidney lesions were compatible with those reported for ochratoxicosis. Mycotoxicological examinations on the incriminated feed revealed that A. flavus and A. terreus (a citrinin producer) were the predominant fungi in the ration. However, A. ochraceus could not be isolated, neither could ochratoxin be demonstrated in the mouldy feed. The disease syndrome could also not be reproduced experimentally by dosing pigs with pure cultures of the A. flavus and A. terreus isolates.
It appears that 200 μg/kg of OA is the lowest level at which development of porcine nephropathy is possible in the course of four to five months.82 Citrinin at levels of 200–400 mg/kg feed is required for the development of porcine nephropathy.56 On the basis of the incidence of OA-contaminated cereal samples, Krogh et al.82 and Carlton and Krogh23 regard OA as the main cause of porcine nephropathy, whereas citrinin seems to be of minor importance.
The toxicological response to OA varies with the dose, duration of exposure and animal species.23 The most important clinical signs associated with chronic ochratoxicosis in swine include reduced food intake, loss of body weight, depression, polydipsia and polyuria.23, 35, 155, 156 The mortality rate is usually low.81 In addition to the abovementioned clinical signs, acute intoxication is characterized by ataxia, diarrhoea and subcutaneous oedema and many animals die within one to five days.81, 155 The haematological changes in acute and chronically affected pigs are increased serum urea and creatinine values, progressive leucocytosis, neutrophilia and a relative lymphopaenia.155, 156 At higher doses of OA, there may be a multifocal necrotizing gastroenteritis, oedema, haemorrhage and necrosis of lymphoid tissues, as well as degeneration and necrosis in the kidneys and liver.23 However, spontaneous disease in pigs is most often associated with prolonged exposure to low doses of OA, in which case the kidney is often the only organ affected. Macroscopically, the kidneys may be enlarged or smaller than normal, shrunken and pale tan in colour, with multifocal, slightly sunken, whitish streaks distributed particularly in the cortex. In some cases, there may also be small cysts in the cortex and a perirenal oedema.35, 86, 87 The proximal convoluted tubules have been shown to be the target part of the nephron to be affected in ochratoxicosis.51, 128 Ochratoxin A causes a reduction in the activities of the enzymes, NADH-tetrazolium reductase and succinate dehydrogenase, in the tubular epithelium; these enzymes are believed to cause the impairment of the function and morphological changes in this part of the nephron.51 Depending on the dose and duration of exposure to the toxin, the kidney lesions may vary in severity from mild degenerative changes (cloudy swelling and hydropic degeneration) in the epithelial cells of proximal convoluted tubules to more severe degeneration and necrosis with cytolysis and desquamation of the epithelium. Marked interstitial and periglomerular fibrosis, accompanied by atrophic and degenerative changes, as well as karyomegaly in the epithelium of the proximal convoluted tubules, tubular dilatation and sclerosis and hypercellularity of glomeruli occur in pigs after prolonged exposure to low doses of OA.23, 35, 86, 155, 156
Ribelin129 reviewed the literature on ochratoxicosis in cattle and came to the conclusion that, apart from experimental poisoning in calves, no proven cases of ochratoxicosis in cattle have been reported. Lloyd, Daniels and Stahr92 reported nephrosis in cattle in the USA, probably related to OA and citrinin poisoning. Cattle are more resistant to OA poisoning, because the toxin is degraded by bacteria in the rumen to non-toxic ochratoxin and phenylalanine.4, 67, 77
Residues of OA in carcases pose a possible public health problem. They are greatest in the kidneys and, in declining order, in lean meat, the liver and fat.84–86, 97 In Denmark, carcases are condemned when the content of OA exceeds 25 μg/kg in the kidney.97 If OA-containing feed is replaced by non-OA feed some time prior to slaughter, the residues decrease rapidly.97 Balkan (endemic) nephropathy, which is a fatal chronic kidney disease affecting rural populations in areas of Bulgaria, Romania and Yugoslavia, has been associated with the consumption of pork containing residues of OA.81, 84
Secondary Nephropathy
Degeneration and/or necrosis of the epithelium, especially of the proximal convoluted tubules in the kidneys, can be regarded as rather non-specific changes. These changes often develop secondarily to a range of infectious diseases; can be part of many inorganic and organic toxicoses; accompany haemolytic and rhabdomyolytic conditions; and are prominent in most hepatogenous photosensitivity conditions in ruminants.
In South Africa, there are good examples of nephrosis in stock following secondarily on plant or mycotoxin-induced disease. Enzootic icterus is a chronic copper poisoning of sheep in certain parts of the Karoo, probably resulting from the ingestion of plants containing relatively high levels of copper (see Haemopoietic system). Apart from signs and changes compatible with a stress-related haemolytic crisis, the kidneys are always markedly enlarged, friable, and have a gun-metal colour. Microscopically, there is evidence of a haemoglobinuric/ischaemic nephrosis, characterized by tubular degeneration; the accumulation of varying sized haemoglobin and protein droplets, bile pigments, lipofuscin and haemosiderin especially in the proximal convoluted tubular epithelium; and numerous haemoglobin and proteinaceous casts in tubuli in the cortex and medulla.
In addition to the liver lesions associated with hepatogenous photosensitivity in ruminants, the kidneys are usually slightly to moderately swollen and yellowish-brown, and the cortices often contain numerous pinpoint cysts as a result of tubular dilatation, giving the kidney surface a somewhat uneven appearance. In more prolonged cases of photosensitivity, especially in geeldikkop and facial eczema, the accumulation of bile pigments in epithelial cells and within the lumen of tubules stain the parenchyma diffusely light green (Figure 17), with minute dark-green spots scattered throughout the cortex. Birefringent crystalloid material which characterizes the hepatic lesions in geeldikkop and Panicum photosensitivity in sheep (see Liver), are sometimes discernible in epithelial cells and in the lumen of some tubules (Figure 18). Apart from being excreted in the bile, sporidesmin is also passed in the urine, where the irritant effect of the mycotoxin is responsible for pyelonephritis and an erosive to ulcerative cystitis in sheep and cattle suffering from pithomycotoxicosis (see Liver). Nephrosis is particularly severe in cattle affected by subacute to chronic Lantana camara poisoning and animals that succumb show elevated serum urea levels and a necrohaemorrhagic inflammation of the small and large intestines.
Hairy vetch (Vicia spp.) poisoning in cattle is associated with multifocal granulomas in the kidneys (Figure 19), as well as in other tissues5, 19, 118 (see The skin and adnexa).
The ingestion of certain plants in the Northern Cape Province and southern parts of Namibia is suspected of being the cause of the yellowish to khaki-brown discolouration of carcases of healthy sheep sometimes reported at abattoirs in this region. Immediately after slaughter, this discolouration is absent or hardly visible, but it becomes more apparent a few hours after exposure to the atmosphere. Apart from a greenish to khaki-brown colour especially of the medulla, the kidneys appear otherwise normal (Figure 20). The liver and the lymph nodes may likewise be pigmented. Special stains revealed that the pigment is lipofuscinous in nature. In Phalaris poisoning a greenish-blue discolouration of the renal medulla and other organs may also be evident (see Central nervous system).
Intoxications Affecting the Urinary Bladder
Pteridium aquilinum (L.) Kühn (Dennstaedtiaceae)
(= Pteris aquilina L.)
Bracken fern, adelaarsvaring
Staggers in horses (see Central nervous system); a haemorrhagic diathesis and bone marrow suppression in cattle (see Haemopoietic system); adenocarcinoma of the small intestine, polioencephalomalacia and progressive retinal degeneration, known as bright blindness in sheep,120, 167 and a neoplastic condition of the urinary bladder referred to as chronic enzootic haematuria in cattle, have been associated with bracken fern poisoning.108, 114, 115 To the best of our knowledge, there are no reports of enzootic haematuria in cattle in South Africa, notwithstanding the widespread occurrence of this plant.
The worldwide incidence of chronic enzootic haematuria in cattle is variable.114, 116 In some cattle herds in British Columbia, Canada, only occasional cases occur, while in others 80–90% of the total population can be affected.114 Pamukcu114 reviewed the epidemiological factors playing a role in urinary bladder tumours in Turkish cattle and came to the conclusion that under field conditions the latent period is usually not less than two and a half years. Pamukcu et al.115 showed that most of the cattle (100–150 kg body mass) that were fed 300–600 g dried plants daily for a mean period of 550 days (276–1 192 days), developed bladder lesions. Feeding of fresh fronds, semi-dried bracken or powdered rhizomes has successfully produced urinary bladder tumours in cattle.115, 125 Ptaquiloside (PT), a potent norsesquiterpenoid (see Central nervous system and Haemopoietic system), has been identified as the major carcinogenic factor in bracken ferns. However, in order to become carcinogenic, PT must first be activated to its unstable dienone form (APT). Since this activation process requires alkaline conditions, it probably explains why the bladder and ileum (with their relatively high pH) are the target organs. APT alkylates mostly the adenine of DNA in a sequence-selective fashion. Carcinogenesis has been attributed to H-ras activation via initial adenine alkylation by the toxin.124, 142
The disease affects cattle, mostly 4–12 year olds, and is characterized by a slow progressive course, showing intermittent haematuria of variable duration, extending from a few days to months or even years.114–116, 125 In some animals with long-standing bladder lesions haematuria may be absent, while in others with minor changes in the bladder the bleeding may be severe.114 Secondary infections or obstruction of the urethra or ureters sometimes complicate the picture.114, 116 Pamukcu et al.116 reported that 20 out of 30 cows that were fed bracken developed bladder tumours in 276–1 192 days. However, all 30 cows showed signs of bracken poisoning, which included multiple haemorrhage in the subcutaneous tissues, alimentary tract, nasal mucosa, heart and lungs, and some also had free blood in the large intestines.
The lateral and ventral parts of the bladder wall that are in constant contact with urine are most often involved, indicating that the carcinogenic substance(s) is in the urine.114, 116 Hyperplastic, metaplastic and neoplastic changes have been reported in affected bladders.114, 116, 125 The neoplasms may be epithelial or mesenchymal in nature, or often mixed types may be present.114, 116 The size, shape and colour of the tumours vary. While some tumours are benign (papillomas, adenomas, haemangiomas, fibromas) others have a more malignant character and include transitional cell carcinomas, squamous cell carcinomas, adenocarcinomas, undifferentiated carcinomas and haemangio-endotheliomas.115, 116, 125 The more malignant tumours may infiltrate the wall of the bladder and only occasionally spread to the iliac and lumbar lymph nodes and the lungs.114, 116, 125
Apart from neoplasms in the urinary tract of cattle, adenocarcinomas in the small intestine of sheep, intestinal adenocarcinomas, sarcomas and urinary bladder carcinomas in rats, a variety of neoplasms of other body systems in different laboratory animals have been associated with the feeding of bracken fern.53, 116, 120, 125
Urinary bladder tumours have been reported in Zebu cattle in Kenya where they did not have access to bracken fern.109 In a separate incident, unrelated to this outbreak, a papilloma-like virus was isolated from urinary bladder tumours of cattle that had not been exposed to bracken.113
Pithomyces chartarum (Berk & Curt.) M.B. Ellis (Fungi: Hyphomycetes)
For the effects of sporidesmin on the urinary bladder, refer to Liver.
Intoxications Affecting the Reproductive System and the Developing Foetus
Salsola tuberculatiformis Botsch. (Chenopodiaceae)
(= S. tuberculata (Fenzl ex Moq.) Schinz var. tomentosa Aellen)
Cauliflower saltwort, blomkoolbossie, blomkoolganna, koolganna, bosganna
Salsola tuberculatiformis is the cause of a syndrome locally known as grootlamsiekte (big-lamb disease) which occurs particularly in Karakul and Karakul-Persian cross-breeds, and is characterized by prolonged gestation and foetal post-maturity.10, 72
The genus Salsola (Figure 21), about 75 species of which are encountered in South Africa, are generally regarded as good grazing. Apart from S. tuberculatiformis, at least five other species, when eaten in sufficient quantities, may produce the syndrome (J. Morgenthal, University of Stellenbosch, personal communication, 1986).
The cauliflower saltwort is a sturdy, densely twigged and woody shrub growing c.150 mm to 1 m high. It may have the appearance of a large cauliflower when it is browsed. The plant can range from brownish-pink, greyish-green, grey, silvery to light brown. Small tubercular leaves are arranged close together, and small membranous, pale-pink flowers, which later turn yellow, are borne at the ends of short branches from September to April (Figure 22). A single, flat, winged seed is found in the small fruits.162 Salsola tuberculatiformis is very drought-resistant and grows in brackish ground, on limestone ridges, in the vicinity of pans, or plains and hill tops, especially in the southern parts of Namibia and Botswana, and in the arid parts of the Western and Northern Cape provinces (Figure 23).162 Although blomkoolganna has a salty or slightly bitter taste it is regarded as a valuable pasture plant in these dry habitats.162
Outbreaks of grootlamsiekte are almost invariably associated with severe droughts. Basson et al.10 did many feeding trials on sheep at various stages of gestation and were able to induce the disease only when the plant was fed to ewes during the last 50 days of pregnancy. Later, Joubert et al.72 showed that, in sheep that received the leaves of the plant, the insult proved to be mainly during the last 50 days of pregnancy. On the other hand, sheep in the first 50 days of pregnancy were especially susceptible to the disease when the twigs were fed to them. They also showed that the feeding of the plant for only ten days prior to normal term could result in mild prolongation of gestation.72 Joubert et al.72 concluded that the daily ingestion of 900 g of the plant for at least 10–50 days during any stage of gestation can result in post-maturity.
In times of severe drought, the incidence of disease varies from about three to 33%.10 Apart from the gestation period, which may be slightly prolonged or be as long as 213 days, the only other clinical signs in ewes at parturition are poorly developed udders and abdominal distension (Figure 24).10 Some of the ewes developed hydramnios or oligoamnios. At parturition the majority of ewes suffered from dystocia because of the large size of the lambs, and many of the ewes were assisted or slaughtered for humane reasons. It has been shown that the birth weight of most lambs at early post-maturity is normal or even slightly reduced, before a steady increase in mass followed.10, 72 Some lambs attained a birth weight of c.12 kg (normal birth weight is c.4 kg). From a practical viewpoint the problem is further accentuated by the fact that Karakul lambs are slaughtered on the day of birth specifically to obtain optimal curl in the pelt. A few days’ delay, as in prolonged gestation, results in a loss of the curl and makes the pelts unacceptable to furriers.
According to Basson et al.,10 most of the macro- and microscopical features of post-maturity in lambs referred to by Holm65 were present in cases of grootlamsiekte. These included large skeletal frame, eruption of teeth (Figure 25), overgrowth of the epidermal structures, such as hair and hooves, adrenal and adenohypophysial atrophy, Leydig cell hypoplasia, advanced follicular development of the foetal ovaries (Figure 26), external meconium staining, lethargy, poor suckling ability and high neonatal mortality. Additional observations in lambs affected with grootlamsiekte were atrophy of the thymus, inactivity of the thyroid, enlargement of the female genitalia, mild testicular hypoplasia and light-olive green to almost greenish-black pigmentation particularly of the liver, kidneys and lymph nodes, but also of the bones and lungs. Basson et al.10 did a detailed histochemical study on this pigment and found that is was lipoproteinaceous in nature and made up of meconial bile pigments. These workers described similar pigments in normal late-term foetuses and new-born lambs.
In post-term ewes the lesions were more or less limited to the genitalia.10 Apart from small and non-lactating udders, the ovaries were inactive, showing only few or no follicular developments, while functional and regressed corpora lutea were frequently absent. The foetal membranes and the amniotic fluid, which were either depleted or increased, were often olive green.
Basson et al.10 measured progesterone and cortisol levels in a control and Salsola group of pregnant ewes. They found that the progesterone concentration was significantly higher in the Salsola group than in the control animals during the last trimester of gestation. The discrepancy in the cortisol concentrations of the two groups became evident at 110 days of pregnancy, when the levels of the Salsola group continued to increase, while the cortisol values of the control ewes started to drop.
Basson et al.10 speculated that the growth of the placenta may be retarded and/or placental steroid biosynthesis impaired by a principle in the plant. They also raised the point that the shrub may have a luteotrophic effect and that the luteal function may have been maintained longer than normal. These workers are of the opinion that atrophy of the adenohypophysis and adrenals of the foetus in grootlamsiekte are of major significance in prolonged gestation. Furthermore, it is suspected that S. tuberculatiformis inhibits the hypothalamic releasing factors which regulate the secretion of most adenohypophysial hormones. These include the follicle stimulating hormone and luteinizing hormone which may ultimately play a role in suppression of the oestrus cycle and development of the Leydig cells, respectively.
Partus induction with stilboestrol and oxytocin in ewes up to 170 days of gestation proved to be successful.72 In ewes beyond this stage of pregnancy, the results were poor mainly because of the large size of the lambs, overgrown pelts, the small amount of foetal fluids and the less favourable response of the ewes at this stage to drugs. An interval of 24 hours between the administration of stilboestrol and oxytocin should be allowed. After parturition, antibiotics should be administered to prevent metritis, which can kill 10% of the ewes.72
Trifolium spp. (Fabaceae)
T. pratense L.
Red clover, rooiklawer
T. repens L.
White clover, witklawer
T. subterraneum L.
Subterranean clover
Trifolium spp., (Figure 27) especially T. subterraneum, are widely sown in Australia to improve pastures,36 but in South Africa, where stock graze mostly extensively, this farming practice is not as popular. The southern Winter Rainfall Area of the Western Cape Province is an exception and clover pastures are often used there for sheep. Subterranean clover is going out of favour to some extent and only clovers that have been proven low in oestrogenic activity are utilized. Consequently, the oestrogenic infertility syndrome, referred to as clover disease, induced by these plants, plays an almost negligible role in reproductive disturbances in sheep in our subcontinent, in contrast to Australia where severe economic losses are incurred annually by its use.36
Subterranean, red and white clovers contain oestrogenic glycosides, namely the isoflavones (formononetin, genistein, biochanin A, diadzein), whereas coumestans (coumestrol, 4l-O-methylcoumestrol) are the oestrogenic compounds in Medicago sativa (lucerne) and M. truncatula (barrel medic).36 In South Africa, dry land lucerne is used extensively in the southern Western Cape Province, and unexpectedly low conception rates occur from time to time in sheep, possibly as a result of the coumestans (R.A. Wilson, Caledon, personal communication, 1986).
Formononetin, the main compound producing biological effects in sheep, has little oestrogenic activity. However, after ruminal metabolism it yields mainly the oestrogenic metabolite, equol36(Figure 28). On the other hand, genestein and biochanin A are themselves oestrogenic when given parenterally, but are metabolized to inactive compounds in the rumen.36 More than 0,3% formononetin on a dry weight basis in clovers is hazardous to sheep.36
Depressed fertility, associated with cystic glandular hyperplasia of the cervix and uterus, occurs in sheep grazing pastures with high oestrogenic levels.36, 161 Even if the ewes are taken off the oestrogenic pastures, infertility, referred to by some authorities as ‘permanent infertility’ will still persist for a long time.36 Ewes may be similarly affected if mated when the clover has dried off and the pastures are of low oestrogenicity and green clover is grazed later in the season after mating has taken place.36 A major factor in ewes affected with this kind of infertility is the increased amount and fluidity of the cervical mucus, which limits the number of sperm entering the cervix.144 This results in poor sperm penetration to the oviducts and a low incidence of fertilization.36, 144
In addition there may be a higher than normal loss of embryos in the first two months after mating.36, 54, 161 While some authorities reported normal oestrous cycles and ovulations in affected ewes, others have shown a significant increase in variability of oestrous cycle duration.3 ‘Temporary infertility’ has been reported in ewes that are mated while grazing highly oestrogenic clover.36 Decreased fertility occurs at that mating, but does not persist in subsequent years if sheep are grazed on nonoestrogenic pastures.36 This infertility is most probably a result of a depressed fertilization rate and a disturbance in the transport rate of ova through the oviducts.66 Phytooestrogens have no effect on the fertility of rams36 and only occasionally affect cattle.46
The principal lesions in ewes suffering from clover disease occur in the cervix and uterus and include glandular hyperplasia and reduction in the amount of stratified epithelium in the cervix, cystic endometrial hyperplasia and occasionally also hydrometra and pyometra.1, 3, 36, 62, 73 Bacterial infections of the reproductive tract are suggested to be more common in ewes affected with clover disease.1, 3
Apart from infertility in ewes, other manifestations have been associated with oestrogenic pastures in sheep, including dystocia attributable to reduced myometrial tone at parturition; uterine prolapse in maiden, non-pregnant and post-partum ewes; blunting of the labia of the vulva and hypertrophy of the clitoris and the tissue overlying it; mammary gland development and lactation in non-pregnant ewes and wethers; squamous metaplasia, hyperplasia and cystic dilatation of the bulbourethral glands and urethral obstruction in wethers due to epithelial hyperplasia and cellular casts and sediment containing 4l-O-methylequol; and prolapse of the rectum in wethers.2, 36, 73, 112
Teat enlargement has been reported to be a sensitive index of the potency of pastures.16 A range of cultivars low in isoflavones, particularly formononetin, have been developed. Through management and agronomic measures, the severe form of clover disease is now not commonly seen in Australia.36 The oestrogenic activity of pastures has been shown to be higher in winter and early spring, reduced when the clover is wilted or dried naturally, but the potency is retained if clovers are dried artificially.73
Apart from agronomic methods to control the disease, research is also being directed at the immunization of animals against phyto-oestrogens, and at the genetic selection of sheep for resistance to clover disease, to alter phytooestrogen metabolism or to administer oestrogen antagonists or blocking agents.36 Apart from phyto-oestrogens, hyperoestrogenism in gilts in South Africa and abroad has been associated with the mycotoxin, zearalenone, produced by the fungus Fusarium graminearum (= F. roseum).
Fusarium graminearum Schwabe (Fungi: Hyphomycetes)
Hyperoestrogenism
Porcine oestrogenism associated with the mycotoxin, zearalenone (F-2) and its metabolite zearalenol, occurs worldwide27, 88 and has also been reported in South Africa.9
As a result of different systems of taxonomy and nomenclature, the incriminated fungus (Fusarium roseum) has been referred to as F. roseum ‘Graminearum’, F. roseum ‘Equisiti’, F. roseum ‘Culmorum’, F. graminearum or Giberella zeae.27, 88, 98, 105, 106 The oestrogenic mycotoxins, zearalenone and zearalenol, as well as eight of the trichothecenes, including deoxynivalenol, nivalenol and possibly other unknown toxins, are formed by some strains of F. graminearum.27, 88, 98, 105, 106 Under laboratory conditions, small quantities of zearalenone may also be produced by other Fusarium spp., such as F. sporotrichioides (F. tricinctum) and F. verticillioides (= F. moniliforme).27, 88, 105 The main toxin, zearalenone (Figure 29), has an empirical formula of C18H22O5 and has the generic name of 6-(10-hydroxy-6-oxo-trans-l-undecenyl) ß-resorcyclic acid-α-lactone.27 Zearalenol has been found in contaminated maize (Figure 30) and it also plays a role in the oestrogenism syndrome in swine.27, 106 It has been demonstrated that zearalenone is metabolized by rumen bacteria and protozoa to α- and ß-zearalenol, which are more oestrogenic for the host animal than zearalenone.77, 106 Zearalenone also interferes with the normal metabolism of steroids in the liver, because hydroxysteroid dehydrogenase, which is normally involved in the metabolism of steroids, also mediates the conversion of zearalenone to zearalenol.77 Zearalenone is relatively heat stable and has a phenolic configuration in contrast to endogenous sex hormones, which have a steroidal structure.88 According to Kiang et al.76 and Kiessling et al.77 zearalenone and its derivatives act by binding to specific oestrogen receptor proteins of mammals and by competing for binding sites with oestradiol.
Most outbreaks of hyperoestrogenism have been associated with excessive rainfall in the autumn followed by storage of high-moisture ear maize in open cribs through the winter months before it is fed during late winter or early spring.9, 27, 29, 88, 105 During this time, low temperatures and alternating moderate to low temperatures favour growth and toxin production of this pinkish-white fungus.27, 88 The greatest portion of zearalenone in nature is formed by the phytopathogen, F. graminearum, on high-moisture ear maize, either in plants left standing in the field where infection is especially favoured by wet, cool conditions during the silking stage ‘baard stadium’, or in unshelled ears stored in places exposed to rain in winter.27, 29 Infected ears show a pinkish rot progressing from the tip of the ear downwards. Zearalenone is a stable compound, and therefore the longer maize on the cob is stored, the more toxic it will be.88 Sometimes the Fusarium fungi may be absent in a sample of feed, but zearalenone may still be present.88 There is no record of zearalenone being formed de novo in high-moisture shelled maize, possibly because zearalenone-producing Fusarium spp. do not compete well with other fungi that invade this type of shelled maize.27 According to Christensen,27 some varieties of maize are more susceptible than others to this kind of cob rot or headblight.
Zearalenone has been found in maize, wheat, barley, oats, grain sorghum, etc.27, 88, 94 This toxin has been detected in mouldy maize from various parts of southern Africa.88, 99–101 In the summer of 1979, outbreaks of porcine oestrogenism occurred in the mist belt of the KwaZulu-Natal midlands.9 In an outbreak near Ixopo the pigs had been fed a mixed ration (0,95 mg/kg zearalenone) prepared from mouldy home-grown yellow maize (10 mg/kg zearalenone) heavily infected by F. graminearum. On another farm, near Winterton, similar but milder signs developed after the pigs had eaten a ration into which maize (0,8 mg/kg zearalenone) had been incorporated. No zearalenone could be demonstrated in samples of the mixed ration. In the first outbreak, all of the 350 young pigs (25–28 kg) were affected, and in the second outbreak 80% of growing pigs (40 kg) developed signs.9
Zearalenone fed to pigs at a level of 1–5 mg/kg (ppm) in maize, caused tumefaction of the vulva in gilts (Figure 31).20, 88 Clinical signs of oestrogenism usually occur 5–8 days after consumption of contaminated feed89 and include hyperaemia and oedema of the vulva, slight turbid discharge from the vulva, enlargement of the mammary glands and nipples, and in severe cases, also prolapse of the vagina and rectum owing to mucosal irritation and straining and relaxation of the rectal sphincter muscles.9, 17, 27, 29, 88, 94, 105 Oedema of the external urethral orifice may result in difficult micturition. The morbidity is high and may approach 100%, but the mortality is usually low.9, 27, 88 Clinical signs disappear approximately seven days after withdrawal of the contaminated feed.88
Oestrogenism occurs most often in prepubertal gilts, possibly because the endocrine system in the young is deficient or is not fully developed and thus does not interfere with effects of zearalenone.88 Similar signs have also been reported in mature female swine and nursing piglets.17, 94, 96, 127 In young barrows (castrates) and boars, there are hypertrophy of the mammary glands, swelling of the prepuce, atrophy of the testes and decreased libido.27, 88 Ingestion of zearalenone by pigs has also been associated with infertility of sows, decreased litter size, weakened offspring, mummified foetuses, stillbirths, agalactia, splay legs in new-born piglets, and decreased immunological response.26, 27, 30, 88, 93, 102 Signs of hyperoestrogenism followed a few days later by necrosis of the tail have been observed in new-born piglets suckled by clinically normal sows fed rations contaminated by zearalenone.38
The effect of zearalenone on the ovaries of prepubertal gilts includes ovarian hypoplasia, lack of Graafian follicular development and corpora luteal formation, and degeneration of oocytes.88, 89
Porcine oestrogenism is often referred to as ‘vulvovaginitis’, a misnomer because there are no inflammatory changes in the genital tract, but the alterations are principally physiological in nature and are characterized by interstitial oedema and proliferation and squamous metaplasia of the epithelium in the vagina and cervix.27, 88, 89 There is thickening of the vulva, vagina, cervix and uterus caused by oedema and/or hypertrophy and hyperplasia of the cellular elements comprising the wall of these structures.89 The thickened endometrium is oedematous and the submucosal glands are hyperplastic.
In New Zealand, contamination of pastures by zearalenone42, 43 adversely affects fertility of ewes.146, 160 High levels of zearalenone were demonstrable in samples of Fusarium-infected pastures associated with infertility, while α-and ß-zearalenol (metabolites of zearalenone) could be detected in the urine of affected sheep. According to surveys, the high zearalenone levels coincided with the sheep breeding season when exposure to the toxin would have greatest effect.42, 43, 52, 146, 160 Dosing trials with zearalenone revealed that ≥3 mg per day before mating could depress ovulation rate and lower lambing percentages.145
Bloomquist et al.15 reported enlarged mammary glands in prepubertal dairy heifers after the consumption of ear maize containing zearalenone. Holstein cows that received 25–100 mg/kg zearalenone for 42 consecutive days showed swelling and hyperaemia of the vulva within one week of administration but oestrus and ovulation were not affected.27 Zearalenol is widely used commercially in ear implants to promote the growth of beef cattle.27 Zearalenone and zearalenol are transmitted into the milk of cattle and may be a potential health hazard to humans.104
There is no effective treatment, and like most other mycotoxicoses this condition can be best prevented by avoidance of spoiled feed. The storage of maize on the cob under moist conditions should be discouraged.
Other Plants and Mycotoxins
Reproductive disorders in livestock worldwide have mostly been associated with infectious causes, giving rise to infertility, embryonal death, resorption, mummification, abortion, stillbirth or the birth of weak off-spring with or without congenital defects.
For many years, most of the congenital defects have been attributed to hereditary factors, but with growing interest in this field it became apparent that most of the foetal and neonatal congenital neurogenic anomalies (hydrocephalus, hydranencephaly, porencephaly, micrencephaly, cerebellar hypoplasia, etc.) in ruminants are the result of transplacental viral infections, which include the bluetongue virus (wild-type and modified viruses), Akabane virus, mucosal disease/viral diarrhoea virus, Wesselsbron disease virus (wild-type and attenuated viruses) and with the mouse brain-attenuated Rift Valley fever virus.34, 121 Apart from teratogenic viruses, certain anthelmintics belonging to the benzimidazole group have been associated with skeletal abnormalities and sometimes also with hydrocephalus and cerebral hypoplasia in newborn lambs whose dams were dosed in the first 60 days of pregnancy.126
In recent years, some reproductive disorders in stock have been ascribed to plant poisonings and mycotoxicoses. Apart from phytogenous and mycotoxin-induced oestrogenism, especially in sheep and pigs, other toxins, mostly abroad, are responsible for infertility and reproductive disturbances in stock. In the USA, Lupinus sericeus, L. caudatus and L. laxiforus, which contain the alkaloidal teratogen, anagyrine, cause congenital crooked calf disease, characterized by arthrogryposis, scoliosis or kyphosis, torticollis and cleft palate, if pregnant cows ingest the plant between 40 and 70 days of gestation.74 The piperidine alkaloids, coniine and (α-coniceine), of the North American plant, Conium maculatum, are responsible for skeletal defects in calves when the plant is fed to cows during the fiftieth to seventy-fifth days of gestation,74 and similar deformities have been reported in piglets of sows that were fed with the plant between 43 and 61 days of pregnancy.119 Three steroidal alkaloids (jervine, cyclopamine and cycloposine) of the plant Veratrum californicum, growing in certain parts of the USA, cause congenital cyclopia and cephalic deformities in lambs,14 when pregnant ewes ingest the plant on the fourteenth day of gestation.74 Outbreaks of congenital arthrogryposis in piglets unassociated with nicotine were reported after pregnant sows had consumed tobacco stalks in the USA.37, 74 Nicotiana glauca, containing anabasine, is widespread in southern Africa and has been associated experimentally with congenital skeletal deformities, such as fixed excessive carpal flexure (arthrogryposis), lordosis, cleft palate and deformed head in lambs born from ewes that received the plant between 30 and 60 days of gestation.75 Abortion, as well as foetal skeletal deformities and neurovisceral vacuolation, have been reported with locoism in sheep and cattle in North America following the ingestion of locoweed (Astragalus and Oxytropis spp.) during pregnancy.59 The cytoplasmic vacuolation in many foetal and maternal tissues with locoweed poisoning is very similar to that seen with Swainsona poisoning in Australia and with the inherited lysosomal storage disease, mannosidosis, particularly in Aberdeen Angus cattle.59 Morris and Lee107 reviewed the literature on the toxicity and teratogenicity of Solanaceae glycoalkaloids, particularly those of the potato (Solanum tuberosum), and found evidence that some of the alkaloids cause congenital teratology (mostly cranial abnormalities) in laboratory animals. They pointed out that green potatoes may be potentially hazardous to pregnant women.
Ingestion of the needles of the pondorosa pine tree (Pinus pondorosa) in the USA results in embryonal loss, abortion, calf mortality and retained placenta in cattle,21, 110, 148 especially in the last trimester of gestation. A diterpene acid, isocupressic acid, has been implicated as the abortifacient compound.57 Isocupressic acid has also been detected in a number of other genera including Cupresses and Juniperus spp.57
In South Africa, the bulbous plant, Dipcadi glaucum150 (see Central nervous system) and the pods of the tree, Acacia nilotica157 (see Haemopoietic system) have been reported as a cause of abortion in sheep and goats, respectively.
Nitrate poisoning in stock occurs worldwide and has been associated with a variety of crop plants, weeds, grasses, chemicals and water (see Haemopoietic system). Generally, toxicity is of an acute nature, affecting mostly cattle and sheep, following the intake of high levels of nitrate over a relatively short time. A high percentage of animals will die after exhibiting typical signs of poisoning. However, pregnant animals that survive the acute episode often abort.18, 24, 39, 141
From available literature it would seem that abortion, especially in the last trimester of pregnancy in cattle and sheep, is often associated abroad with subclinical or chronic nitrate poisoning.25, 71, 140, 141 In fact Case25 stressed that if the abortion could not be proven to be of infectious origin, the possibility of subclinical nitrate poisoning should be investigated. Cows that abort appear healthy apart from a somewhat roughened coat and lowered milk production. In the USA, this type of poisoning has been reported in cattle on rations of silage and legume hay (lucerne) and also on chopped fresh forage, such as Sudan grass and maize.25 Placental anoxia as a result of maternal methaemoglobinaemia, the fact that foetuses and neonates are apparently more susceptible to methaemoglobin formation,18, 71 as well as decreased luteal synthesis of progesterone, have been put forward as explanations.50 Aborted foetuses are often autolytic, and in these cases the ocular fluid appears to be the most suitable specimen to confirm a diagnosis of nitrate poisoning.71
Apart from hereditary goitre in stock,73, 137 goitrogenic activity has been demonstrated in a wide range of cruciferous plants and in some clover and grass species.132, 133, 147, 164 Most parts of these plants, but especially the seeds of the Brassica spp., contain glucosinolates (formerly known as thioglucosides) which are hydrolysed to organic nitriles and isothiocyanates that may be deleterious if consumed under certain conditions.164 Inclusion of linseed cake, kale, rape and other goitrogenic plants in the diet of pregnant cows, ewes and does may result in resorption, abortion or the birth of weak offspring showing signs of cretinism, such as enlarged thyroid glands, dwarfing, obesity, hair loss and skin changes, skeletal malformations, mental retardation and sluggishness.11, 132, 133, 147, 154
Bath et al.11 reported an outbreak of goitre and hypothyroidism in the Graaff-Reinet district in new-born Angora kids whose mothers grazed irrigated fertilized lucerne pastures during their entire gestation period. Reports from Zimbabwe disclosed that pregnant ewes that grazed on highly fertilized star grass pastures (Cynodon plectostachyus) during summer months gave birth in autumn to lambs with goitre.132 Some of the lambs were hairless, post-natal mortality was high and many of them showed skeletal deformities, such as bent forelegs and overshot mandibles. Analyses of the pastures revealed that they were marginally deficient in iodine and rich in cyanogenic glycosides. Pregnant ewes were also pastured on five different grass species that were heavily fertilized with nitrogen.133 Neonatal goitre and skeletal deformities occurred with four of these grasses, Cynodon nlemfuensis cv Mugugu, C. aethiopicus cv No. 2, Panicum coloratum cv Bushmen mine and Paspalum dilatatum cv Paraguay. Thiocyanate resulting from the endogenous detoxification of cyanide is the goitrogen in this instance (see Haemopoietic system).
To the best of our knowledge, no mycotoxin has yet been linked with congenital teratology in stock, but some fungal metabolites, such as ochratoxin A and aflatoxin B1,49 cause a range of teratogenic defects of skeletal and soft tissues, including cranio-facial anomalies (exencephaly, anophthalmia, microphthalmia, etc.) and impairment of maturation and morphological differentiation of organs, such as the thymus, pulmonary alveoli, cardiac muscle, etc. in baby mice whose mothers received either of the toxins on the eighth or the ninth day of gestation.8, 23 Similar congenital skeletal and soft-tissue defects occurred in mice after T-2 toxin administration to their mothers.103 The trichothecenes,63, 64 T-2 toxin and deoxynivalenol, were reported to be responsible for abortion in swine after intravenous administration, but these fungal metabolites did not result in abortion in pigs when added to their diets. Infertility, reduced litter size and weak piglets were noted in sows that received T-2 toxin before conception.170, 171 In South Africa, Schneider et al.136 reported abortions in some of the pregnant ewes affected by stachybotryotoxicosis, a trichothecene intoxication.
Perinatal losses (stillborn or non-viable lambs and calves) have occurred in dams exposed to Stenocarpella maydis (diplodiosis) during the second and especially the third trimester of gestation (see Central nervous system).
For many years ergotism in stock has been ascribed by stockmen and veterinarians as a cause of abortion, but according to Christensen,28 who reviewed the literature, the case for this is not strong and he concluded that abortion is seldom a feature of ergot poisoning.
Discussion
Uraemia, sometimes also referred to as azotaemia, is a clinical syndrome of renal failure associated with a range of disturbances, such as interference of fluid volume regulation; disturbances in electrolyte balance; acid-base imbalance; failure to excrete metabolic wastes, such as urea and creatinine; and disturbances in endocrine function. Death in animals may be attributed to different factors, but metabolic acidosis, hyperkalaemia and/or hypocalcaemia may be severe enough to be fatal.73 It would appear that cattle, in contrast to non-ruminants, can survive longer periods after bilateral nephrectomy, possibly because urea is recycled in the rumen.168 In an experiment where both kidneys of four bullocks were removed, the plasma urea rose at a mean rate of 53 mg/100 ml/day and was accompanied by a large rise in plasma creatinine over a period of up to seven days post-surgery.168 Apart from hypochloraemia in these animals, there were no significant rises in plasma potassium, inorganic phosphate and uric acid, no evidence of severe acidosis and all animals remained in a relatively good clinical condition over the anuric period before they were slaughtered.
According to Jubb et al.,73 external lesions resulting from uraemia occur inconstantly, but are more predictable in dogs where the gastrointestinal, cardiovascular, respiratory and skeletal systems are involved. In uraemic cattle there is often a colitis, and the wall of the rumen, abomasum, small and large intestines, as well as the mesentery, are oedematous. On opening, especially of the abomasum and large intestines, ammonia may be smelled. Myoarteritis (fibrinoid degeneration and necrosis of the muscular layer of the blood vessel wall) is evident in the affected colon wall.
In South Africa, changes compatible with uraemia, such as oedematous, haemorrhagic and necrotic lesions in the alimentary tract, have been noted in cattle suffering from poisonings by Quercus spp.111, 134 and Lantana camara (N. Fourie and S. Newsholme, VRI, unpublished observations, 1985) and with the overdosing of the babesiacidal drugs, amicarbalide and imidocarb.40
Circumstantial evidence indicates that Salsola barbata (soutgannabos) may be the cause of a nephrotic syndrome in sheep in certain areas of the Northern Cape Province. According to P. Jordaan, State Veterinarian, Upington, the droughts of the 1960s motivated farmers in the Kenhardt district to furrow dried vlei beds to promote the growth of S. barbata as feed for their sheep. As a result of the good rainy seasons of 1975 to 1976 the water table lifted, giving rise to serious salination of the soil which further favoured the soutgannabos. During subsequent droughts, grazing became sparse and the diet of the sheep consisted almost exclusively of this plant.
Salsola barbata would appear to be harmless at times, while at other times outbreaks of poisoning occur one to four weeks after sheep have been put on soutgannaveld. Affected animals are listless and show subcutaneous oedema of the ventral parts of the throat, thorax and abdomen. At necropsy the kidneys are swollen, friable and mottled a yellowish-brown. Microscopically, the kidney lesions comprise a range of degenerative changes (cloudy swelling, hydropic degeneration and hyaline droplet degeneration), as well as necrosis of especially the proximal convoluted tubular epithelium and certain glomerular changes (mesangial proliferation and adhesions between visceral and parietal layers of the Bowman’s capsule). Other noteworthy changes include effusion of the body cavities (sometimes several litres of ascitic fluid), severe oedema of particularly the abomasal folds, but also of the caecum, colon and rectum, and in more severe cases diarrhoea and occasionally prolapse of the rectum have been noted. On removal of affected animals from soutgannaveld the subcutaneous oedema subsides, but the sheep emaciate progressively and ultimately die. This nephrotic syndrome has so far been reported only in Dorpers grazing on soutgannaveld.
A sheep that received two doses of air-dried S. barbata at a level of 10 g/kg on alternate days was destroyed in extremis on the fourth day of the experiment (P. Jordaan, State Veterinarian, Upington, unpublished observations, 1985). At necropsy the kidneys were swollen and mottled greyish-brown, while there was microscopical evidence that the animal had died of an oxalic nephrosis which could possibly be ascribed to unrealistically high doses of plant material.
References
- ADAMS, N.R. 1976. Pathological changes in the tissues of infertile ewes with clover disease. Journal of Comparative Pathology, 86, 29–35.
- ADAMS, N.R. 1979. Masculinisation of the external genitalia in ewes with clover disease. Australian Veterinary Journal, 55, 22–24.
- ADAMS, N.R., LIGHTFOOT, R.J. & CHARLICK, A.J. 1975. The duration of the oestrus cycle of ewes affected with clover disease. Australian Veterinary Journal, 51, 306–309.
- ALLISON, M.J. 1978. The role of ruminal microbes in the metabolism of toxic constituents from plants. pp. 101–118. In: KEELER, R.F., VAN KAMPEN, K.R. & JAMES, L.F. (eds.) Effects of poisonous plants on livestock. New York, San Francisco, London: Academic Press.
- ANDERSON, C.R. & DIVERS, .J. 1983. Systemic granulomatous inflammation in a horse grazing hairy vetch. Journal of the American Veterinary Medical Association, 183, 569–570.
- ANDERSON, A., MOUNT, E., VRINS, A. & ZIEMER, L. 1983. Fatal acorn poisoning in a horse: Pathologic findings and diagnostic considerations. Journal of the American Veterinary Medical Association, 182, 1105–1110.
- ANDREWS, .J. 1971. Oxalate nephropathy in a horse. Journal of the American Veterinary Medical Association, 159, 49–52.
- ARORA, G. 1985. Experimental mycotoxicosis: Some observations on the teratopathological effects of a single dose of aflatoxin B1 and ochratoxin A in CBA/CA mice. pp. 537–544. In: LACEY, J. (ed.) Trichothecenes and other mycotoxins. Proceedings of the international mycotoxin symposium, Sydney, Australia, 1984. Chilhester, New York, Brisbane, Toronto, Singapore: John Wiley & Sons.
- AUCOCK, H.W., MARASAS, F.O., MEYER, J. & CHALMERS, P. 1980. Field outbreaks of hyperoestrogenism (vulvo-vaginitis) in pigs consuming maize infected by Fusarium graminearum and contaminated with zearalenone. Journal of the South African Veterinary Association, 51, 163–166.
- BASSON, P.A., MORGENTHAL, J.C., BILBROUGH, R.B., MARAIS, J.K., KRUGER, S.P. & VAN DER MERWE, J.L. DE B. 1969. ‘Grootlamsiekte’, a specific syndrome of prolonged gestation in sheep caused by a shrub, Salsola tuberculata (Fenzl ex Moq.) Schinz var. tomentosa C.A. Smith ex Aellen. Onderstepoort Journal of Veterinary Research, 36, 59–104.
- BATH, G.F., WENTZEL, D. & VAN TONDER, E.M. 1979. Cretinism in angora goats. Journal of the South African Veterinary Association, 50, 237–239.
- BAUER, J., GAREIS, M. & GEDEK, BRIGETTE. 1984. Zum nachweis und vorkommen van ochratoxin A bei Schlachtschweinen. Berliner & Münchener Tierärztliche Wochenschrift, 97, 279–283.
- BECK, J.L. & BECK, C.C. 1972. Acorn toxicity in a heifer. Veterinary Medicine/Small Animal Clinician, September, 1003–1006.
- BINNS, W., SHUPE, J.L., KEELER, F. & JAMES, L.F. 1965. Chronological evaluation of teratogenicity in sheep fed Veratrum californicum. Journal of the American Veterinary Medical Association, 147, 839–842.
- BLOOMQUIST, C., DAVIDSON, J.N. & PEARSON, E.G. 1982. Zearalenone toxicosis in prepubertal dairy heifers. Journal of American Veterinary Medical Association, 180, 164–165.
- BRADEN, A.W.H., SOUTHCOTT, W.H. & MOULE, G.R. 1964. Assessment of oestrogenic activity of pastures by means of increase of teat length in sheep. Australian Journal of Agricultural Research, 15, 142–152.
- BRISTOL, F.M. & DJURIKOVIC, S. 1971. Hyperestrogenism in female swine as the result of feeding mouldy corn. The Canadian Veterinary Journal, 12, 132–135.
- BUCK, W.B., OSWEILER, G.D. & VAN GELDER, G.A. 1982. Nitrates, nitrites and related problems. pp. 109–115. In: Clinical and Diagnostic Veterinary Toxicology. 2nd ed. Iowa, USA: Kendall/Hunt Publishing Company.
- BURROUGHS, G.W., NESER, J.A., KELLERMAN, T.S. & VAN NIEKERK, F.A. 1983. Suspected hybrid vetch (Vicia villosa crossed with Vicia dasycarpa) poisoning of cattle in the Republic of South Africa. Journal of the South African Veterinary Association, 54, 75–79.
- CALDWELL, R.W. & TUITE, J. 1970. Zearalenone production in field corn in Indiana. Phytopathology, 60, 1696–1697.
- CALL, J.W. & JAMES, L.F. 1978. Pine needle abortion in cattle. pp. 587–590. In: KEELER, R.F., VAN KAMPEN, K.R. & JAMES, L.F. (eds.) Effects of poisonous plants on livestock. New York, San Francisco, London: Academic Press.
- CARLSON, J.R. & BREEZE, R.G. 1984. Ruminal metabolism of plant toxins with emphasis on indolic compounds. Journal of Animal Science, 58, 1040–1049.
- CARLTON, W.W. & KROGH, P. 1979. Ochratoxins. A review. pp. 165–288. In: Conference on mycotoxins in animal feeds and grains related to animal health. US Department of Commerce. National Technical Information Service PB–300 300. Food and Drug Administration, Rockville, Maryland, USA.
- CARRIGAN, M.J. & GARDNER, I.A. 1982. Nitrate poisoning in cattle fed sudax (Sorghum sp. hybrid) hay. Australian Veterinary Journal, 59, 155–157.
- CASE, A.A. 1957. Some aspects of nitrate intoxication in livestock. Journal of the American Veterinary Medical Association, 130, 323–329.
- CHANG, G., KURTZ, H.J. & MIROCHA, C.J. 1979. Effects of the mycotoxin zearalenone on swine reproduction. American Journal of Veterinary Research, 40, 1260–1267.
- CHRISTENSEN, C.M. 1979. Zearalenone. pp. 1–79. In: Conference on mycotoxins in animal feeds and grains related to animal health. US Department of Commerce, National Technical Information Service PB–300 300. Food and Drug Administration Rockville Maryland, USA.
- CHRISTENSEN, C.M. 1980. Ergots. pp. 1–44. In: Conference on mycotoxins in animal feeds and grains related to animal health. US Department of Commerce, National Technical Information Service PB80–221773, Food and Drug Administration, Rockville, Maryland, USA.
- CHRISTENSEN, C.M., NELSON, G.H. & MIROCHA, C.J. 1965. Effect on the white rat uterus of a toxic substance isolated from Fusarium. Applied Microbiology, 13, 653–659.
- CIEGLER, A. 1975. Mycotoxins: Occurrence, chemistry, biological activity. Lloydia, 38, 21–35.
- CLARK, E.G. & COTCHIN, E. 1956. A note on the toxicity of the acorn. British Veterinary Journal, 112, 135–139.
- CLARKE, MYRA, L., HARVEY, D.G. & HUMPHREYS, D.J. 1981. Veterinary Toxicology. 2nd edn. London: Baillière Tindall.
- COCKRILL, J.M. & BEASLEY, J.N. 1979. Renal damage to cattle during acorn poisoning. Veterinary Medicine/Small Animal Clinician, 74, 82–85.
- COETZER, J.A.W. & SCHUTTE, A.P. 1978. Besmetlike oorsake van perinatale vrektes by herkouers. Journal of the South African Veterinary Association, 49, 89–98.
- COOK, W.O., OSWEILER, G.D., ANDERSON, T.D. & RICHARD, J.L. 1986. Ochratoxicosis in Iowa swine. Journal of the American Veterinary Medical Association, 188, 1399–1402.
- COX, R.I. 1978. Plant estrogens affecting livestock in Australia. pp. 451–464. In: KEELER, R.F., VAN KAMPEN, K.R. & JAMES, L.F. (eds.) Effects of poisonous plants on livestock. New York: Academic Press.
- CROWE, M.W. 1978. Tobacco – a cause of congenital arthrogryposis. pp. 419–427. In: KEELER, R.F., VAN KAMPEN, K.R. & JAMES, L.F. (eds.). Effects of poisonous plants on livestock. New York, San Francisco, London: Academic Press.
- DACASTO, M., ROLANDO, P., NACHTMANN, C., CAPPA, L. & NEBBIA, C. 1995. Zearalenone mycotoxicosis in piglets suckling sows fed contaminated grain. Veterinary and Human Toxicology, 37, 359–361.
- DAVIDSON, W.B., DOUGHTY, J.L. & BOLTON, J.L. 1941. Nitrate poisoning of livestock. Canadian Journal of Medicine and Veterinary Science, 5, 303–313.
- DE VOS, A.J., BARROWMAN, P.R., COETZER, J.A.W. & KELLERMAN, T.S. 1978. Amicarbalide: A therapeutic agent for anaplasmosis. Onderstepoort Journal of Veterinary Research, 45, 203–208.
- DICKIE, C.W., HAMANN, M.H., CARROLL, W.D. & CHOW, F. 1978. Oxalate (Rumex venosus) poisoning in cattle. Journal of the American Veterinary Medical Association, 173, 73–74.
- DIMENNA, M.E., LAUREN, D.R., POOLE, P.R., MORTIMER, P.H. HILL, R.A.& AGNEW, M.P. 1987. Zearalenone in New Zealand pasture herbage and the mycotoxin-producing potential of Fusarium species from pastures. New Zealand Journal of Agricultural Research, 30, 499–504.
- DIMENNA, M.E., LAUREN, D.R., SPROSEN, J.M. & MACCLEAN, K.S. 1991. Fusarium and zearalenone on herbage fractions from short and from long pastures. New Zealand Journal of Agricultural Research, 34, 445–452.
- DOLLAHITE, J.W., HOUSHOLDER, G.T. & CAMP, B.J. 1966. Effect of calcium hydroxide on the toxicity of post oak (Quercus stellata) in calves. Journal of the American Veterinary Medical Association, 148, 908–912.
- DOLLAHITE, J.W., PIGEON, R.F. & CAMP, B.J. 1962. The toxicity of gallic acid, pyrogallol, tannic acid and Quercus havardi in the rabbit. American Journal of Veterinary Research, 23, 1264–1267.
- DONALDSON, L.E. 1983. Clover disease in two Missisippi cattle herds. Journal of the American Veterinary Medical Association, 182, 412–413.
- DU PLESSIS, E.C. 2004. Pathological investigation of the nephrotoxic effects of the shrub Nolletia gariepina (DC) Mattf. in cattle. MMedVet (Path) dissertation, University of Pretoria.
- DU PLESSIS, E.C., JOUBERT, J.P.J., PROZESKY, L., NAUDÉ, T.W., HERMAN, P., VAN DER WESTHUIZEN, G.B.M. 2004. Nephrotic syndrome in cattle caused by the shrub Nolletia gariepina in the Kalahari Sandveld of South Africa. pp. 76–77. In: ACAMOVIC, T, STEWART, C.S. & PENNCOTT, T.W. (eds.) Poisonous plants and related toxins. Wallingford: CABI Publishing.
- EDDS, G.T. 1979. Aflatoxins. pp. 80–164. In: Conference on mycotoxins in animal feeds and grains related to animal health. US Department of Commerce, National Technical Information Service PB–300 300. Food and Drug Administration, Rockville, Maryland, USA.
- EL BAHRI, L., BELGUITH, J., BLOUIN, A. 1997. Toxicology of nitrates and nitrites in livestock. The Compendium of Continuing Education for the Practising Veterinarian: Food Animal Section, 19, 643–648.
- ELLING, F. 1977. Demonstration of ochratoxin A in kidneys of pigs and rats by immunofluorescence microscopy. Acta Pathologica et Microbiologica Scandinavica, Section A, 85, 151–156.
- ERASMUSON, A.F., SCAHILL, B.G. & WEST, D.M. 1994. Natural zeranol (a-zearalenol) in the urine of pasture-fed animals. Journal of Agricultural and Food Chemistry, 42, 2721–2725.
- EVANS, I.A. & MASON, J. 1965. Carcinogenic activity of bracken. Nature, 208, 913–914.
- FELS, H.E. & NEIL, H.G. 1968. Effects on reproduction of prolonged grazing of oestrogenic pastures by ewes. Australian Journal of Agricultural Research, 19, 1059–1068.
- FOWLER, M.E. & RICHARDS, W.P.C. 1965. Acorn poisoning in a cow and a sheep. Journal of the American Veterinary Medical Association, 147, 1215–1220.
- FRIIS, P., HASSELAGER, E. & KROGH, P. 1969. Isolation of citrinin and oxalic acid from Penicillium viridicatum West and their nephrotoxicity in rats and pigs. Acta Pathologica et Microbiologica Scandinavica, 77, 559–560.
- GARDNER, D.R., PANTER, K.E., JAMES, L.F., STEGELMEIER, B.L., PFISTER, J.A. 1998. Diterpene acid chemistry of ponderosa pine and implications for late-term induced abortions in cattle. pp. 339–344. In: GARLAND, T. & BARR, A.C. (eds.) Toxic plants and other natural toxicants. Wallingford: CAB International.
- GIBBS RUSSELL, G.E., WATSON, L., KOEKEMOER, M., SMOOK, L., BARKER, N.P., ANDERSON, H.M. & DALLWITZ, M.J. 1991. Memoirs of the Botanical Survey of South Africa No. 58. Grasses of Southern Africa. South Africa: Botanical Research Institute.
- HARTLEY, W.J. 1978. A comparative study of darling pea (Swainsona spp.) poisoning in Australia with locoweed (Astragalus and Oxytropis spp.) poisoning in North America. pp. 363–369. In: KEELER, R.F., VAN KAMPEN, K.R. & JAMES, L.F. (eds.) Effects of poisonous plants on livestock. New York, San Francisco, London: Academic Press.
- HENDERSON, M. & ANDERSON, J.G. 1966. Common weeds in South Africa. Memoirs of the Botanical Survey of South Africa, 37. Department of Agricultural Technical Services, Republic of South Africa.
- HERWEIJER, C.H. & DEN HOUTER, L.F. 1971. Poisoning due to fat hen (Chenopodium album) in sheep. Netherlands Journal of Veterinary Science, 4, 52–53.
- HEYDON, R.A. & ADAMS, N.R. 1977. Histochemical studies on cervical glands in ewes with clover disease. Journal of Comparative Pathology, 87, 353–361.
- HINTIKKA, E.L. 1978. Stachybotryotoxicosis in swine. pp. 268–273. In: WYLLIE, T.D. & MOREHOUSE, L.G. (eds.) Mycotoxic fungi, mycotoxins, mycotoxicoses. An encyclopedic handbook. Vol. 2, New York and Basel: Marcel Dekker, Inc.
- HINTIKKA, E.L. 1978. Stachybotryotoxicosis in cattle and captive animals. pp. 152–161. In: WYLLIE, T.D. & MOREHOUSE, L.G. (eds.) Mycotoxic fungi, mycotoxins, mycotoxicoses. An encyclopedic handbook. Vol. 2. New York and Basel: Marcel Dekker, Inc.
- HOLM, L.W. 1967. Prolonged pregnancy. Advances in Veterinary Science, 11, 159–205.
- HOLST, P.J. & BRADEN, A.W.H. 1972. Ovum transport in the ewe. Australian Journal of Biological Science, 25, 167–173.
- HULT, K., TEILLING, A. & GATENBECK, S. 1976. Degradation of ochratoxin A by a ruminant. Applied Environmental Microbiology, 32, 443–444.
- JAMES, L.F. 1968. Serum electrolyte, acid-base balance and enzyme changes in acute Halogeton glomeratus poisoning in sheep. Canadian Journal of Comparative Medicine and Veterinary Science, 32, 539–543.
- JAMES, L.F. 1978. Oxalate poisoning in livestock. pp. 139–145. In: KEELER, R.F., VAN KAMPEN, K.R. & JAMES, L.F. (eds.) Effects of poisonous plants on livestock. New York: Academic Press.
- JAMES, L.F., STREET, J.C. & BUTCHER, J.E. 1967. In vitro degradation of oxalate and of cellulose by rumen ingesta from sheep fed Halogeton glomeratus. Journal of Animal Science, 26, 1438–1444.
- JOHNSON, J.L., SCHNEIDER, N.R., KELLING, C.L. & DOSTER, A.R. 1983. Nitrate exposure in perinatal beef calves. American Association of Veterinary Laboratory Diagnosticians, 26th Annual Proceedings, 167–180.
- JOUBERT, J.P.J., BASSON, P.A., LUCKS, H.J. & BURGER, J.H.S. 1972. ‘Grootlamsiekte’, a specific syndrome of prolonged gestation in sheep: Further investigations. Onderstepoort Journal of Veterinary Research, 39, 59–70.
- JUBB, K.V.F., KENNEDY, P.C. & PALMER, N. 1985. Pathology of domestic animals. 3rd edn., Vol. 3. Orlando, Florida: Academic Press, Inc.
- KEELER, R.F. 1978. Alkaloid teratogens from Lupinus, Conium, Veratrum and related genera. In: KEELER, R.F., VAN KAMPEN, K.R. & JAMES, L.F. (eds.) Effects of poisonous plants on livestock. New York, San Francisco, London: Academic Press.
- KEELER, R.F. & CROWE, M.W. 1984. Teratogenicity and toxicity of wild tree tobacco, Nicotiana glauca in sheep. Cornell Veterinarian, 76, 50–59
- KIANG, D.T., KENNEDY, B.J., PATHRE, S.V. & MIROCHA, C.J. 1978. Binding characteristics of zearalenone analogs to estrogen receptors. Cancer Research, 38, 3611–3615.
- KIESSLING, K.H., PETTERSON, H., SANDHOLM, K. & OLSEN, MONICA. 1984. Metabolism of aflatoxin, ochratoxin, zearalenone and three trichothecenes by intact rumen fluid, rumen protozoa and rumen bacteria. Applied and Environmental Microbiology, 47, 1070–1073.
- KINGSBURY, J.M. 1964. Poisonous plants of the United States and Canada. New Jersey: Prentice-Hall, Inc. Englewood Cliffs.
- KITCHEN, D.N., CARLTON, W.W. & TUITE, J. 1977. Ochratoxin A and citrinin induced nephrosis in beagle dogs. I. Clinical and clinicopathological features. Veterinary Pathology, 14, 154–172.
- KITCHEN, D.N., CARLTON, W.W. & TUITE, J. 1977. Ochratoxin A and citrinin induced nephrosis in beagle dogs. II. Pathology. Veterinary Pathology, 14, 261–272.
- KROGH, P. 1978. Mycotoxicosis in swine. pp. 236–256. In: WYLLIE, T.D. & MOREHOUSE, L.G. (eds.) Mycotoxic fungi, mycotoxins, mycotoxicoses. An encyclopedic handbook. Vol. 2. New York: Marcel Dekker, Inc.
- KROGH, P., HALD, B. & PETERSEN, J.E. 1973. Occurrence of ochratoxin A and citrinin in cereals associated with mycotoxin porcine nephropathy. Acta Pathologica et Microbiologica Scandinavica, Section B, 81, 689–695.
- KROGH, P., HASSELAGER, E. & FRIIS, P. 1970. Studies on fungal nephrotoxicity. 2. Isolation of two nephrotoxic compounds from Penicillium viridicatum Westling: citrinin and oxalic acid. Acta Pathologica et Microbiologica Scandinavica, Section B, 78, 401–413.
- KROGH, P., HALD, B., PLESTINA, R. & CEOVIC, S. 1977. Balkan (endemic) nephropathy and foodborn ochratoxin A: Preliminary results of a survey of foodstuffs. Acta Pathologica et Microbiologica Scandinavica, Section B, 85, 238–240.
- KROGH, P., ELLING, F., GYRD-HANSEN, N., HALD, B., LARSEN, A.E., LILLEHOJ, E.B., MADSEN, A., MORTENSEN, H.P. & RAVNSKOV, U. 1976. Experimental porcine nephropathy: Changes of renal function and structure perorally induced by crystalline ochratoxin A. Acta Pathologica et Microbiologica Scandinavica, Section A, 84, 429–434.
- KROGH, P., ELLING, F., FRIIS, C., HALD, B., LARSEN, A.E., LILLEHOJ, E.B., MADSEN, A., MORTENSEN, H.P., RASMUSSEN, F. & RAVNSKOV, U. 1979. Porcine nephropathy induced by longterm ingestion of ochratoxin A. Veterinary Pathology, 16, 466–475.
- KROGH, P., AXELSEN, N.H., ELLING, F., GYRDHANSEN, N., HALD, B., HYLDGAARD-JENSEN, J., LARSEN, A.E., MADSEN, A., MORTENSEN, H.P., MOLLER, T., PETERSEN, O.K., RAVNSKOV, U., ROSTGAARD, M. & AALUND, O. 1974. Experimental porcine nephropathy. Acta Pathologica et Microbiologica Scandinavica, Section A, 246, 1–21.
- KURTZ, H.J. & MIROCHA, C.J. 1978. Zearalenone (F2) induced estrogenic syndrome in swine. pp. 256–268. In: WYLLIE, T.D. & MOREHOUSE, L.G. (eds.) Mycotoxic fungi, mycotoxins, mycotoxicoses. An encyclopedic handbook. Vol. 2. New York and Basel: Marcel Dekker, Inc.
- KURTZ, H.J., NAIRN, M.E., NELSON, G.H., CHRISTENSEN, C.N. & MIROCHA, C.J. 1969. Histologic changes in the genital tracts of swine fed estrogenic mycotoxin. American Journal of Veterinary Research, 30, 551–556.
- LILLEHOJ, E.B. & GORANSSON, B. 1980. Occurrence of ochratoxin and citrinin producing fungi on developing Danish barley grain. Acta Pathologica et Microbiologica Scandinavica, Section B, 88, 133–137.
- LITTLEDIKE, E.T., JAMES, L. & COOK, H. 1976. Oxalate (halogeton) poisoning of sheep: Certain physiopathologic changes. American Journal Veterinarian Research, 37, 661–666.
- LLOYD, W.E., DANIELS, G.N. & STAHR, H.M. 1985. Cases of nephrotoxic mycotoxicoses in cattle and swine in the United States. pp. 545–548. In: Trichothecenes and other mycotoxins. Proceedings of the international mycotoxin symposium, Sydney, Australia.
- LONG, G.G., DIEKMAN, M., TUITE, J.F., SHANNON, G.M. & VESONDER, R.F. 1982. Effect of Fusarium roseum corn culture containing zearalenone on early pregnancy in swine. American Journal of Veterinary Research, 43, 1599–1603.
- McERLEAN, B.A. 1952. Vulvovaginitis of swine. The Veterinary Record, 64, 539–540.
- McKENZIE, R.A., BELL, A.M., STORIE, G.J., KEENAN, F.J., CORNACK, K.M. & GRANT, S.G. 1988. Acute oxalate poisoning of sheep by buffel grass (Cenchrus ciliaris). Australian Veterinary Journal, 65, 26.
- McNUTT, S.H., PURWIN, P. & MURRAY, C. 1928. Vulvovaginitis in swine. Journal of the American Veterinary Medical Association, 73, 484.
- MADSEN, A., MORTENSEN, H.P. & HALD, B. 1982. Feeding experiments with ochratoxin A contaminated barley for bacon pigs. 1. Influence on pig performance and residues. Acta Agriculture Scandinavica, 32, 225–239.
- MARASAS, W.F.O., NELSON, P.E. & TOUSSON, T.A. 1985. Taxonomy of toxigenic fusaria. pp. 3–14. In: LACEY, J. (ed.) Trichothecenes and other mycotoxins. Proceedings of the international mycotoxin symposium, Sydney, Australia. Chickester, New York, Brisbane, Toronto, Singapore: John Wiley & Sons.
- MARASAS, W.F.O., VAN RENSBURG, S.J. & MIROCHA, C.J. 1979. Incidence of Fusarium species and the mycotoxins, deoxynivalenol and zearalenone, in corn produced in esophageal cancer areas in Transkei. Journal of Agriculture and Food Chemistry, 27, 1108–1112.
- MARASAS, W.F.O., KRIEK, N.P.J., VAN RENSBURG, S.J., STEYN, M. & VAN SCHALKWYK, G.C. 1977. Occurrence of zearalenone and deoxynivalenol, mycotoxins produced by Fusarium graminearum Schwabe, in maize in southern Africa. South African Journal of Science, 73, 346–349.
- MARTIN, P.M.D. & KEEN, P. 1978. The occurrence of zearalenone in raw and fermented products from Swaziland and Lesotho. Sabauroudia, 16, 15–22.
- MILLER, J.K., HACKING, A., HARRISON, J. & GROSS, V.J. 1973. Stillbirths, neonatal mortality, and small litters in pigs associated with the ingestion of Fusarium toxin by pregnant sows. The Veterinary Record, 93, 555–559.
- MIROCHA, C.J. 1979. Trichothecene toxins produced by Fusariums. pp. 289–373. In: Conference on mycotoxins in animal feed and grains related to animal health. US Department of Commerce, National Technical Information Service PB–300 300. Food and Drug Administration, Rockville, Maryland, USA.
- MIROCHA, C.J., PATHRE, S.V. & ROBINSON, T.S. 1979. Comparative metabolism of zearalenone and transmission into bovine milk. Proceedings of the 4th international IUPAC symposium on mycotoxins and phycotoxins, Lausanne, Switzerland, 29–31 August, 1979. Chemische Rundschau 32 (No 36): E501.
- MIROCHA, C.J., PAWLOSKY, R.J., TONG–XIA, Z. & LEE, Y.W. 1985. Chemistry and biological activity of Fusarium roseum mycotoxins. pp. 291–305. In: LACEY, J. (ed.) Trichothecenes and other mycotoxins. Proceedings of the international mycotoxins symposium, Sydney, Australia. Chichester, New York, Brisbane, Toronto, Singapore: John Wiley & Sons.
- MIROCHA, C.J., SCHAUERHAMER, B., CHRISTENSEN, C.M., NIKU-PAAVOLA, M.L. & NUMMI, M. 1979. Incidence of zearalenol (Fusarium mycotoxin) in animal feed. Applied and Environmental Microbiology, 38, 749–750.
- MORRIS, S.C. & LEE, T.H. 1984. The toxicity and teratogenicity of Solanaceae glycoalkaloids, particularly those of the potato (Solanum tuberosum): A review. Food Technology in Australia,36, 118–124.
- MUGERA, G.M. & NDERITO, P. 1968. Tumours of the urinary bladder and liver associated with enzootic haematuria in Kenyan cattle. The Veterinary Record, 83, 457–458.
- MUGERA, G.M., NDERITO, P. & SORHEIM, A.O. 1969. The pathology of urinary bladder tumours in Kenya Zebu cattle. Journal of Comparative Pathology and Therapeutics, 79, 251–254.
- NEFF, T.E., ADAMS, C.J. & JACKSON, L.L. 1982. Pathological effects of pine needle ingestion in pregnant mice. Cornell Veterinarian, 72, 128–136.
- NESER, J.A., COETZER, J.A.W., BOOMKER, J. & CABLE, H. 1982. Oak (Quercus robur) poisoning in cattle. Journal of the South African Veterinary Association, 53, 151–155.
- NOTTLE, M.C. & BECK, A.B. 1972. Urinary sediment in sheep feeding on oestrogenic clover. III. The identification of 4’–O–methyl equol as a major component of some sediment. Australian Journal of Agricultural Research, 25, 509–514.
- OLSON, C., PAMUKCU, A.M. & BROBST, D.F. 1965. Papilloma-like virus from bovine urinary bladder tumours. Cancer Research, 25, 840–849.
- PAMUKCU, A.M. 1963. Epidemiologic studies on urinary bladder tumours in Turkish cattle. Annals of the New York Academy of Sciences, 108, 938–947.
- PAMUKCU, A.M., GOKSOY, S.K. & PRICE, J.M. 1967. Urinary bladder neoplasms induced by feeding bracken fern (Pteris aquilina) to cows. Cancer Research, 27, 917–924.
- PAMUKCU, A.M., PRICE, J.M. & BRYAN, G.T. 1976. Naturally occurring and brackenfern-induced bovine urinary bladder tumors. Veterinary Pathology, 13, 110–122.
- PANCIERA, R.J. 1978. Oak poisoning in cattle. pp. 499–506. In: KEELER, R.F., VAN KAMPEN, K.R. & JAMES, L.F. (eds.) Effects of poisonous plants on livestock. New York: Academic Press.
- PANCIERA, R.J. 1978. Hairy vetch (Vicia villosa Roth) poisoning in cattle. pp. 555–563. In: KEELER, R.F., VAN KAMPEN, K.R. & JAMES, L.F. (eds.) Effects of poisonous plants on livestock. New York: Academic Press.
- PANTER, K.E., KEELER, R.F. & BUCK, W.B. 1985. Congenital skeletal malformations induced by maternal ingestion of Conium maculatum (poison hemlock) in newborn pigs. American Journal of Veterinary Research, 46, 2064–2066.
- PARKER, W.H. & McCREA, C.T. 1965. Bracken (Pteris aquilina). Poisoning of sheep in the North York Moors. The Veterinary Record, 77, 861–865.
- PARSONSON, I.M., DELLA-PORTA, A.J. & SNOWDON, W.A. 1981. Developmental disorders of the fetus in some arthropod-borne virus infections. American Journal of Tropical Medicine and Hygiene, 30, 660–673.
- PECKHAM, J.C. 1978. Ochratoxicosis in poultry. pp. 301–307. In: WYLLIE, T.D. & MOREHOUSE, L.G. (eds.) Mycotoxic fungi, mycotoxins, mycotoxicoses. An encyclopedic handbook. Vol. 2. New York: Marcel Dekker, Inc.
- PIGEON, R.F., CAMP, B.J. & DOLLAHITE, J.W. 1962. Oral toxicity and polyhydroxyphenol moiety of tannin isolated from Quercus havardii (skin oak). American Journal of Veterinary Research,23, 1268–1270.
- PRAKASH, A.S., PEREIRA, T.N., SMITH, B.L., SHAW, G. & SEAWRIGHT, A.A.A. 1996. Mechanism of bracken fern carcinogenesis: Evidence of H-ras activation via initial adenine alkylation by ptaquiloside. Natural-Toxins, 4, 221–227.
- PRICE, J.M. & PAMAKCU, A.M. 1968. The induction of neoplasms of the urinary bladder of the cow and the small intestine of the rat by feeding bracken fern (Pteris aquilina). Cancer Research, 28, 2247–2251.
- PROZESKY, L., JOUBERT, J.P.J. & EKRON, M.D. 1981. Paralysis in lambs caused by overdosing with parbendazole. Onderstepoort Journal of Veterinary Research, 48, 159–167.
- PULLAR, E.M. & LEREW, W.M. 1937. Vulvovaginitis of swine. Australian Veterinary Journal, 13, 28.
- PURCHASE, I.F.H. & THERON, J.J. 1968. The acute toxicity of ochratoxin A to rats. Food and Chemical Toxicology, 6, 479–483.
- RIBELIN, W.G. 1978. Ochratoxicosis in cattle. pp. 28–36. In: WYLIE, T.D. & MOREHOUSE, L.G. (eds.) Mycotoxic fungi, mycotoxins, mycotoxicoses. An encyclopedic handbook. Vol 2. New York: Marcel Dekker, Inc.
- RIMINGTON, C. 1933. Chemical investigations of some South African poisonous plants. Onderstepoort Journal of Veterinary Science and Animal Industry, 1, 455–456.
- RIMINGTON, C. & STEYN, D.G. 1933. Psilocaulon absimile N.E. Br. as a stock poison. Onderstepoort Journal of Veterinary Science and Animal Industry, 1, 456–468.
- RODEL, M.G.W. 1971. Neonatal goitre and skeletal deformities in autumn born lambs on Star grass pastures. Rhodesian Agricultural Journal, 68, 109–110.
- RODEL, M.G.W. 1972. Effects of different grasses on the incidence of neonatal goitre and skeletal deformities in autumn born lambs. Rhodesian Agricultural Journal, 69, 59–60.
- SALISBURY, R.M., HARTLEY, W.J., McINTOSH, I.G., HANSEN, N.F., TE PUNGA, W.A. & JAMIESON, S. 1961. A mucosal-like syndrome of cattle in New Zealand. Bulletin O.I.E.
- SCHNEIDER, D.J. 1978. Fatal ovine nephrosis caused by Anagallis arvensis L. Journal of the South African Veterinary Association, 49, 321–324.
- SCHNEIDER, D.J., MARASAS, W.F.O., KUYS, J.C.D., KRIEK, N.P.J. & VAN SCHALKWYK, G.C. 1979. A field outbreak of suspected stachybotryotoxicosis in sheep. Journal of the South African Veterinary Association, 50, 73–81.
- SCHULZ, K.C.A. & GROENEWALD, J.W. 1983. The familial incidence of ‘grey’ Afrikander calves with and without goitre. Journal of the South African Veterinary Association, 54, 147–154.
- SEAWRIGHT, A.A., GROENENDYK, S. & SILVA, K.I.N.G. 1970. An outbreak of oxalate poisoning in cattle grazing Setaria sphacelata. Australian Veterinary Journal, l46, 293–296.
- SHUPE, J.L. & JAMES, L.F. 1969. Additional physiopathologic changes in Halogeton glomeratus (oxalate) poisoning in sheep. Cornell Veterinarian, 59, 41–55.
- SIMON, J., SUND, J.M., WRIGHT, M.J. & DOUGLAS, F.D. 1959. Prevention of non-infectious abortion in cattle by weed control and fertilization practices on lowland pastures. Journal of the American Veterinary Medical Association, 135, 315–317.
- SIMON, J., SUND, J.M., DOUGLAS, F.D., WRIGHT, M.J. & KOWALEZYK, T. 1959. The effect of nitrate or nitrite when placed in the rumens of pregnant dairy cattle. Journal of the American Veterinary Medical Association, 135, 311–314.
- SMITH, B.L., SHAW, G., PRAKASH, A. & SEAWRIGHT, A.A. 1994. Studies on DNA adduct formation by ptaquiloside, the carcinogen of bracken ferns (Pteridium spp.). In: COLEGATE, S.M. & DORLING, P.R. (eds-in-chief) ALLEN, J.G., HUXTABLE, C.R., MEAD, R.J. & PANTER, K.E. (assoc. eds.) Plant-associated toxins: Agricultural, phytochemical and ecological aspects, 167–172: CAB International.
- SMITH, H.A. 1959. The diagnosis of oak poisoning. Southwestern Veterinarian, 13, 34–36.
- SMITH, J.F. 1971. Studies on ovine infertility in agricultural regions of Western Australia, cervical mucus production by fertile and infertile ewes. Australian Journal of Agricultural Research,22, 523–529.
- SMITH, J.F., DI MENNA, M.E. & MCGOWAN, L.T. 1990. Reproductive performance of Coopworth ewes following oral doses of zearalenone before and after mating. Journal of Reproduction and Fertility, 89, 99–106.
- SMITH, J.F., DI MENNA, M., TOWERS, N. & SPROSEN, J. 1991. Zearalenone and Fusarium – what and where it is and its effects on reproductive performance in sheep. Proceedings of the Ruakura Farmers’ Conference 1991, No. 43, 194–198.
- SMYTH, P.J. 1977. The toxic hazards of some pasture plants and vegetables to ruminant animals. Irish Veterinary Journal, 6, 175–179.
- STEVENSON, A.H., JAMES, L.F. & CALL, J.W. 1972. Pineneedle (Pinus pondorosa)-induced abortion in range cattle. Cornell Veterinarian, 62, 519–524.
- STEYN, D.G. 1931. Recent investigations into the toxicity of known and unknown poisonous plants in the Union of South Africa. 17th Report of the Director of Veterinary Service and Animal Industry, 707–727.
- STEYN, D.G. 1932. Investigations into the toxicity of known and unknown poisonous plants in the Union of South Africa. Report on Veterinary Research, Union of South Africa, 18, 871–891.
- STEYN, D.G. 1934. The toxicology of plants in South Africa. South Africa: Central News Agency Limited.
- STEYN, D.G. 1949. Vergiftiging van mens en dier. Pretoria: Van Schaik Bpk.
- STEYN, P.S. & VAN DER MERWE, K.J. 1966. Detection and estimation of ochratoxin A. Nature, 211, 418.
- STOCKS, D.C., DUNSTER, P.J. & GIBSON, J.A. 1984. Observations of the effects of Rapistrum rugosum on thyroid function. Australian Veterinary Journal, 61, 264–265.
- SZEZECH, G.M., CARLTON, W.W., TUITE, J. & CALDWELL, R.W. 1973. Ochratoxin A toxicosis in swine. Veterinary Pathology, 10, 347–364.
- TAPAI, M.O. & SEAWRIGHT, A.A. 1984. Experimental ochratoxicosis A in pigs. Australian Veterinary Journal, 61, 219–222.
- TERBLANCHE, M., PIENAAR, J.G., BIGALKE, R. & VAHRMEYER, J. 1967. Acacia nilotica (L.) Del. subsp. kraussiana (Benth.) Brenan, as a poisonous plant in South Africa. Journal of the South African Veterinary Medical Association, 38, 57–63.
- THOMAS, A.D. 1931. Actinobacillosis and other complications in sheep which may arise from the feeding of prickly pear (Opuntia sp). 17th Report of the Director of Veterinary Services and Animal Industry of the Union of South Africa, 215–229.
- TOWERS, K.G. 1950. Acorn poisoning in heifers. The Veterinary Record, 62, 74–75.
- TOWERS, N.R. & SPROSEN, J.M. 1993. Zearalenone-induced infertility in sheep and cattle in New Zealand. Proceedings of a symposium on ‘Mycotoxicoses of Grassland Farming’, Hamilton, New Zealand, 22–24 September 1993. New Zealand Veterinary Journal, 41, 223–224.
- TURNBULL, K.E., BRADEN, A.W.H. & GEORGE, J.M. 1966. Fertilization and early embryonic losses in ewes that had grazed oestrogenic pastures for 6 years. Australian Journal of Agricultural Research, 17, 907–917.
- VAHRMEIJER, J. 1981. Poisonous plants of southern Africa that cause stock losses. Cape Town: Tafelberg Publishers Limited.
- VAN DER MERWE, K.J., STEYN, P.S., FOURIE, L., SCOTT, DE B. & THERON, J.J. 1965. Ochratoxin A, a toxic metabolite produced by Aspergillus ochraceus Wilh. Nature, 205, 1112–1113.
- VAN ETTEN, C.H. & TOOKEY, H.L. 1978. Glucosinolates in cruciferous plants. pp. 507–520. In: KEELER, R.F., VAN KAMPEN, K.R. & JAMES, L.F. (eds.) Effects of poisonous plants on livestock. New York, San Francisco, London: Academic Press.
- VAN KAMPEN, K.R. & JAMES, L.F. 1969. Acute halogeton poisoning of sheep: Pathogenesis of lesions. American Journal of Veterinary Research, 30, 1779–1783.
- WALTHALL, J.C. & McKENZIE, R.A. 1976. Osteodystrophia fibrosa in horses at pasture in Queensland: Field and laboratory observations. Australian Veterinary Journal, 52, 11–16.
- WATSON, W.A., BARNETT, K.C. & TERLECKI, S. 1972. Progressive retinal degeneration (bright blindness) in sheep: A review. The Veterinary Record, 91, 665–670.
- WATT, C. & CAMPBELL, J.R. 1970. Biochemical changes following bilateral nephrectomy in the bovine. Research in Veterinary Science, 11, 508–514.
- WATTS, P.S. 1957. Decomposition of oxalic acid in vitro by rumen contents. Australian Journal of Agricultural Research, 8, 266–270.
- WEAVER, G.A., KURTZ, H.J., MIROCHA, C.J., BATES, F.Y., BEHRENS, J.C. & ROBINSON, T.S. 1978. Effects of T–2 toxin on porcine reproduction. Canadian Veterinary Journal, 19, 310–314.
- WEAVER, G.A., KURTZ, H.J., MIROCHA, C.J., BATES, F.Y., BEHRENS, J.C., ROBINSON, T.S. & GIPP, W.F. 1978. Mycotoxin-induced abortions in swine. Canadian Veterinary Journal, 19, 72–74.
- YOUNG, J.A. & JAMES, L.F. 1988. Oxalate poisoning. In: JAMES, L.F., RALPHS, M.H. & NIELSEN, D.B. (eds.) The ecology and economic impact of poisonous plants on livestock production. 261–274. Boulder & London: Westview Press.